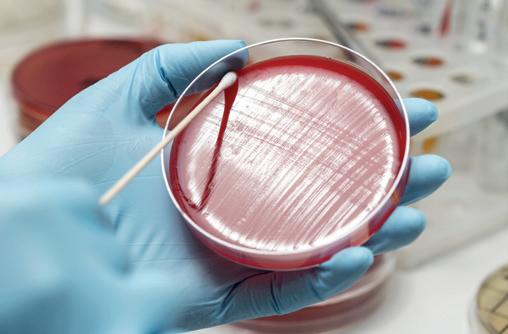

If your horse complains when tightening its girth, paws the ground during meals, yawns quite often, shows difficulty for cantering, consider a possible stomach problem. In that case TWYDIL® STOMACARE helps to carry on with a normal training. The beneficial effect is felt from the first administration. The right time of administration is important because the stomach wall aggression takes place during training. Therefore, give TWYDIL® STOMACARE 15 to 20 minutes before workout.


- Each batch is officially certified by the LCH (following controls on final product, urine and blood)
- Declared content guaranteed until expiry date
TWYDIL® is used by most of the key professionals in the world for over 50 years.

The effort that many across our European readership base has gone to, to support those affected by the ongoing conflict in Ukraine, has simply been amazing.
Trainers, owners and industry suppliers have literally organised horsebox loads of aid, but what can we do on a practical level to support the horsemen and women of Ukraine?
A website has been launched to support those affected by the conflict, but also to highlight the needs which they will have over the coming months.
I’m sharing the text below from the website; please help if you can. “The Ukrainian equestrians and their horses urgently need help to survive and sustain hope through these terrible tragic times.

“Help us to stand for our country and for our values! Being an equestrian means a unique bond between horse and human built on trust. Our commitment to the welfare of our horses is strong at all times and without compromising.”
Mykhaylo Parkhomchuk, General Secretary of the Ukrainian Equestrian FederationThere are more than 100,000 horses in Ukraine, many of the horses are caught up in the war, with no possibility to flee and seek safety, with no shelter and care. Horse owners, riding schools, athletes, breeders, and professionals are in desperate conditions without any resources to save their horses. By making a donation or offering help, you will provide the Ukrainian equestrian community a hope for a better future and save lives of the Ukrainians and their loved ones.
The Ukrainian Equestrian Federation Charity Foundation (registered in Belgium) with the assistance from the FEI (International Equestrian Federation) is supporting the Ukrainian horse owners, riding schools, athletes, equestrian clubs, stables and professionals. We give counselling support and other kinds of needs-based assistance on the ground, including mapping shelter options and assisting with relocation of horses, gathering offers for goods and organising logistics to deliver goods to equestrians and their horses both in Ukraine and/or in their temporary locations in Europe.

We monitor the situation with horses’ welfare and collaborate with FEI and national equestrian federations.



Our promise is that as many funds as possible will be used as direct help for Ukrainian equestrians and their horses in Ukraine (by distributing feed, helping with evacuations and information).



Follow our news to get updates on the activities and the use of donations”.
Lissa Oliver talks to the trainer of the far from easy Flooring Porter and how he achieved Cheltenham festival success.
Mark Rowntree charts Nigel Tinkler’s journey from a jockey to trainer and discovers how his drive and faith in his methods have led to a successful career.


Kerrie Kavanagh looks into some frequently asked questions on how to maintain equine gut health.
What he has achieved in the racing and thoroughbred breeding industry will never be replicated. Daragh Ó Conchúir examines the prolific breeder-trainer’s lasting legacy.
Alysen Miller discovers what we can learn from ‘human’ research into growth and maturation in sport and exercise and why ‘bio banding’ young horses may be more beneficial than grouping by chronological age.
Lissa Oliver talks to industry experts about product labelling and the protocols in place to correctly market the products at our disposal.
Katherine Ford reports on why so many international trainers are choosing to settle in France.

Lissa Oliver looks at the different incentives to race horses across Europe this summer.
trainermagazine.com to download our current digital editions and access back issues of both European and North American Trainer

Fleur Whitlock explains the importance of monitoring infectious diseases and the work undertaken to protect equines.
Ian Wright explains how a new fracture support system will dramatically improve racehorse welfare on British racecourses.
The European Pattern Committee’s new scheme aims to develop the quality of racing in smaller European countries.
The Channel Islands are one of the smallest racing jurisdictions in Europe. Dr Paull Khan talks to those responsible for the management and development of the sport on the islands.
A Kentucky Colt, The Derby, and the rise of the modern thoroughbred industry –James Nicholson tells the story of the first Kentucky-bred (Epsom) Derby winner.
The 2022 Breeders’ Cup World Championships will be hosted by Keeneland in Lexington, KY. Participants in the Breeders’ Cup World Championships are treated to an amazing weekend filled with world-class hospitality, entertainment, and equally incredible racing offering over $31 million in purses and awards, with seven turf races worth $12 million. Pre-entry deadline for all Championship races – Noon, Mon., Oct. 24, 2022

THE
The Win & You’re In global stakes program features graded or group stakes in 11 countries. International starters receive a travel award of $40,000 upon starting in any Championship race. All Win & You’re In Challenge winners receive free entry fees and an automatic selection to the Championships. You can’t win if you’re not in!
Editorial Director/Publisher
Giles Anderson
Sub-Editor
Jana Cavalier
Advert Production
Miranda Filmer
Circulation/Website
Miranda Filmer
Advertising Sales
Giles Anderson
Cover Photograph
Nigel Kirby Photography
Katherine Ford. After completing a degree in languages and the BHA Graduate Development programme, she moved to France for a season with the International Racing Bureau’s Paris office. She then joined French racing channel Equidia’s international department which has taken to racecourses around the world. She now splits her time between Equidia, Sky Sports Racing’s French coverage and freelance writing.
Kerrie Kavanagh is a PhD candidate (through University Of Limerick) where her research focuses on studying the equine microbiome and developing an equine autogenous probiotic. Her work as a Senior Microbiologist at the Irish Equine Centre involves running the Microbiology lab dealing with outbreaks such as Strangles, reproductive venereal pathogens, enteric investigations, parasitology, epidemiology, water & environmental monitoring & disinfectant efficacy trials for equine use.
Paull Khan, PhD. is an international horseracing consultant. He is Secretary-General of the European & Mediterranean Horseracing Federation and Technical Advisor for Europe to the International Federation of Horseracing Authorities. His other clients include the British Horseracing Board. Previously, Dr Khan held many senior roles at Weatherbys, including Banking Director and Racing Director.
Trainer magazine is published by Anderson & Co Publishing Ltd.
This magazine is distributed for free to all ETF members. Editorial views expressed are not necessarily those of the ETF. Additional copies can be purchased for £6.95 (ex P&P). No part of this publication may be reproduced in any format without the prior written permission of the publisher.
Printed in the European Union
For all editorial and advertising queries please contact:
Anderson & Co. Publishing
Tel: +44 (0) 1380 816777
Fax: +44 (0) 1380 816778 email: info@trainermagazine.com www.trainermagazine.com
Issue 77
Alysen Miller is a writer, editor and producer based in London. She has written about racing for publications including The Sunday Times. She launched and produced CNN International’s first dedicated horseracing magazine show, Winning Post. She has ridden on the Flat as an amateur and currently competes in eventing on her retrained racehorse, Southfork.
James C. Nicholson is the author of numerous books including The Kentucky Derby: How the Run for the Roses Became America’s Premier Sporting Event, The Notorious John Morrissey: How a Bare-Knuckle Brawler Became a Congressman and Founded Saratoga Race Course, and Racing for America: The Horse Race of the Century and the Redemption of a Sport. He lives in Versailles, Kentucky.
Daragh Ó Conchúir is a native of Rinn Ó gCuanach, Co Waterford, and a freelance media professional with more than 30 years’ experience of writing and broadcasting in sport, covering a multitude of disciplines and roles for a variety of national and regional organisations. An author of four books, nominee as HWPA Racing Writer of the Year (for Irish and UK racing writers) and reporter for TG4’s acclaimed Rásaí Beo racing coverage.
Lissa Oliver lives in Co. Kildare, Ireland and is a regular contributor to The Irish Field and the Australian magazine, Racetrack. Lissa is also the author of several collections of short stories and two novels
Mark Rowntree is a Northumberland-based Freelance Sports Journalist specialising in Horse Racing Mark contributes regularly to the Racing Post (Spotlights, Comments and Analysis), also working closely with Racing TV/Racing TV International to promote Tote World Pool to a global audience.
Fleur Whitlock BVetMed (Hons) MRCVS qualified from the Royal Veterinary College in 2012 and following an internship in Dubai, she joined the Epidemiology and Disease Surveillance team at the Animal Health Trust. Fleur is part of the team retained by the UK Thoroughbred racing and breeding industry and now works as part of the Equine Infectious Disease Surveillance team (EIDS) at the University of Cambridge. She has recently completed her final year of the Veterinary Epidemiology and Public Health masters at the RVC.
Ian Wright MA VetMB DEO Dipl. ECVS Hon.FRCVS is a surgeon at Newmarket Equine Hospital. He holds the RCVS Diploma in Equine Orthopaedics and is a Diplomate of the European College of Veterinary Surgeons. Recently he co-designed and developed the racecourse fracture support equipment which is being supplied to all British racecourses. In 2016 Ian was awarded Honorary Fellowship of the RVCS in recognition of his contribution to equine surgery.
www.bbag-sales.de

Winner Qatar Prix de l’Arc de Triomphe, Gr.1


Gr.1 winner as 3 and 4yo
Another Arc winner sold at BBAG sales
Spring Breeze Up Sale: 27th May 2022
Entries close: Friday, 22nd April
Premier Yearling Sale: 2nd September 2022
Entries close: Friday, 15th April
October Mixed Sales: 14th and 15th October 2022
Entries close: Monday, 5th September
OWNERS, JOCKEYS AND STABLE STAFF AT THIS YEAR’S CHELTENHAM FESTIVAL™ FROM BOEHRINGER INGELHEIM ANIMAL HEALTH
HENRY DE BROMHEAD, BOODLES CHELTENHAM GOLD CUP CHASE (GRADE 1) WINNING TRAINER 2022.


Horse: A Plus Tard
Owner: Cheveley Park Stud
Jockey: Rachael Blackmore
Groom: Johnny Ferguson
Horse: Honeysuckle
Race: The Unibet Champion Hurdle Challenge Trophy (Grade 1)

Trainer: Henry De Bromhead
Owner: Mr. K Alexander
Jockey: Rachael Blackmore
Grooms: Chloe McNamara & Coleman Comerford
Horse: Energumene
Race: The Betway Queen Mother Champion Steeple Chase (Grade 1)

Trainer: W P Mullins
Owner: Tony Bloom
Jockey: P Townend
Groom: Imran Haider
Horse: Allaho
Race: Ryanair Chase (Grade 1)

Trainer: W P Mullins
Owner: Cheveley Park Stud
Jockey: P Townend
Grooms: Ruth Dudfield & Paul Roche
The TopSpec Trainer of the Quarter award has been won by Gavin Cromwell. Cromwell will receive £1,000 worth of TopSpec feed, supplements and additives as well as a consultation with one of their senior nutritionists.
Lissa Oliver Healy RacingLike many a trainer who has started life via the veterinary college route, County Meathbased Gavin Cromwell was a farrier prior to taking out his licence in 2005. His superb training operation at Danestown, Balrath, includes a 500m round sand and fibre gallop, a 700m circle sand gallop, a schooling strip with both hurdles and fences, a sand ring, schooling ring, horse spa, walkers and plenty of turnout space all year round in both grass and rubber paddocks. The peaceful location provides a relaxing atmosphere for the horses, yet is central for all of Ireland’s racecourses
and within easy travelling distance for his frequent British and French raids.
Cromwell’s big race wins include back-to-back Gr. 1 wins with Jer’s Girl, in the Mares Novice Hurdle Final and Champion Novice Hurdle; Welsh Grand National with the veteran Raz De Maree; Gr. 1 Champion Hurdle at Cheltenham with Espoir D’Allen; and on the Flat, the Gr. 2 Queen Mary Stakes with Quick Suzy, Gr. 2 Prix De Royallieu with Princess Yaiza and the Irish Cambridgeshire with Sretaw.
It is for his achievements at this year’s Cheltenham Festival, however, that he has been awarded Trainer of the Quarter,
ABOVE: Gavin Cromwell and Danny Mullins celebrate after Flooring Porter successfully defended his Stayers’ Hurdle crown on day three of the 2022 Cheltenham Festival.

successfully bringing back the far from straightforward Flooring Porter to retain his crown in the Gr. 1 Stayers Hurdle and only just missing out on a Festival Gr. 1 double when Gabynako ran second to Edwardstone in the Gr. 1 Arkle Challenge Trophy.
Speaking of the successful plan for the repeat Stayers Hurdle win, Cromwell tells us of Flooring Porter, “Rewind to last
year, he had run in a Class B handicap hurdle at Navan in early December and not by design he made all the running, which turned out to suit him. He had his own ideas about things and tried to break the start and ended up going to the front; he won quite impressively by 12 lengths.
“He went up quite a bit in the ratings as a result, so we decided to let him take his chance in the Gr. 1 Christmas Hurdle at Leopardstown and he romped home again. From there he went straight to Cheltenham, where he did the same.
“After that we went to Punchestown, but it didn’t work out for him. He got very lit up pre-race and again at the start, and he doesn’t go right-handed quite as well as he goes left-handed, so he just didn’t run his race.
“Going forward, we tried to keep him left-handed and the whole plan was to go for Cheltenham again, so he was trained accordingly. He went to Navan for the Gr. 2 Lismullen Hurdle and was unfortunate there, as he was going well when he fell. Then on to Leopardstown for the Christmas
Hurdle again and he got left at the start and could never get on terms after that, but he was only beaten a couple of lengths in second. The plan was to go straight to Cheltenham after that and the plan came off.”
Returning to Cheltenham with a previous Festival winner brings with it its own problems, as Cromwell reveals. “There was a little bit more pressure, with him being the reigning champion, but knowing that he hasn’t been straightforward in the past, in the past few months I’ve seen him maturing a lot and I have a lot more confidence in him.
“The immediate future, all being well, he’ll go to Aintree, then he has the option of Auteuil for the French Champion Hurdle 21 May, which we’ll review after Aintree. He won’t go to Punchestown. I’m also quite excited about Gabynako. After he ran second in the Gr. 1 Drinmore Novice Chase and third in the Gr. 1 Faugheen Novice Chase at Limerick, I took the decision to supplement him for the Arkle Trophy. He finished second and now he’s in the Gr. 1 Gold Cup at Fairyhouse, but the Gr. 1 Novice Chase at Punchestown is more likely.”

•
• Efficient digestion and utilisation
• Hoof, skin and coat quality

GOING FORWARD, WE TRIED TO KEEP HIM LEFT-HANDED AND THE WHOLE PLAN WAS TO GO FOR CHELTENHAM AGAIN, SO HE WAS TRAINED ACCORDINGLY.”
GAVIN

The Tinklers have always been synonymous with success, with Nigel’s mother, Marie Delfosse, landing showjumping’s prestigious Queen Elizabeth II Cup at Wembley in 1953 prior to going on to forge a successful career as a point-to-point jockey. His father, Colin Sr, was raised in Nottingham, working as a stable employee to the North London-based Delfosse family before becoming a car dealer in Scarcroft (Leeds) and then a trainer. Older brother Colin Jr—father to jockeys Andrew and Nicky Tinkler—was also drawn to explore the family lifestyle of choice, namely training racehorses.
Nigel explains, “Basically, I knew nothing else other than horseracing from about the age of seven. Watching the Derby and the Grand National became like a drug to me, and my memory could easily chart the entire history of those great races. For the current generation of youngsters, history is often seen as less important than the present, even with the distinct advantage of Google or Wikipedia.”
Since 1666—instigated by King Charles II—the Newmarket Town Plate has been a similarly fiercely contested annual event. With the lure of a string of Newmarket sausages to the winner, Tinkler, then aged 12, first took to the saddle to compete over a demanding three-and three-quarter–mile circuit. Just over three years later, at Sedgefield on Boxing Day 1973, Nimble Joe became Tinkler’s first winner as a fullfledged jockey.
Tinkler went on to notch an impressive 200-plus winners in the saddle, but the lack of a steady income from riding gradually edged him closer toward the training ranks. Citing the frustration of being taken off horses on the biggest of all stages, he says, “I broke a few bones and all, but the main thing I broke was my heart. I probably did too well too early and wasn’t quite mature enough to deal with the bigger jobs. When I was younger, I was quite ignorant—a cocky bastard—although I did have a lot of enthusiasm to improve and learn.”
Initially Tinkler took over the training licence from his father, saddling his first winner over hurdles (Just Jet) at Wolverhampton in early November 1980, but it soon became clear that he needed his own space.
“I decided to move into training and quite honestly thought that with a dozen or so horses, and if I gambled on them, I could earn as much in one day as in one year as a jockey. I didn’t view this as taking a punt; it was more akin to investing, and that’s how I set off as a trainer, buying the yard and building the stables.”
“The property at Langton (near Malton) was a market garden when I bought it for £49,000. I was told that I was crazy, but I couldn’t keep training from Boltby; my father was getting sick of me.”
Four decades have passed since a youthful Nigel Tinkler started training racehorses at Boltby, North Yorkshire. But the unbroken will to succeed through tried and tested methods burns stronger and brighter than ever.Mark Rowntree Nigel Kirby Photography, Eclipse Sportswire
“I looked at yards in Middleham and various other properties elsewhere, including the Camacho’s, Roger Fell’s and Malcolm Jefferson’s; but after a year or so of searching, I settled on Woodland Stables. I’ve never sought to move as I love northern racing; our local racecourses are a lovely way to spend a summer afternoon.”

Tinkler doesn’t seek to mask the fact that gambling played a pivotal role in developing and building the business. “In the early 1980s, I’d be having £2,000 on just four or five horses per year. It was very difficult to lose, and this helped me to build the yard. Ironically, I hardly bet nowadays.”
For the Tinklers, progress didn’t occur by chance. An insightful vision from Colin Sr—long before syndicate ownership was viewed as an acceptable form of ownership—led to the creation, rise and expansion of the Full Circle Syndicate.
“When I first started training, if someone called and said, ‘Can I have a half share in a horse?’, I’d say no, but please do come back when you can afford a full share. Frankly, I was doing alright before my father set up the Full Circle.”
“However, Full Circle provided the opportunity for anyone to buy a horse; my father was well before his time when you look back with Highclere, Middleham Park, Elite Racing and Ontoawinner— all among the current list of successful syndicate operators.”

Tinkler Sr faced an uphill battle in launching the Full Circle Syndicate, having firstly to go to the Jockey Club to seek a change in rules, which at that stage permitted only 12 individuals to own a horse. Shared ownership, even in quarter shares, was considered unusual, and he wanted to have 360 shareholders per horse: hence Full Circle.

Nigel explains; “I said we’d get approximately 100 shareholders— at £450 per year—but after a Cheltenham Festival winner (The Ellier) and a Grand National third (Monamore), we ended up drawing in £13,000!”
Without a shadow of doubt, the rise of the Full Circle Syndicate captured the attention of those closely associated with racing, but perhaps more importantly also the imagination of the general public at large. Far from resting on his laurels, and as outlined by Tinkler Jr, Tinkler Sr was ever so swift in capitalising upon that initial success.
“My father ran a premium-rate tipping line adjacent to Full Circle and was soon receiving weekly dividends of £10,000. For clarity, the Full Circle shareholders had their own ordinary (non-premium rate) telephone number to call for private and confidential information.”
“In those days, before a bar was placed on such premiumrate services, people were simply going to work and calling the tipping line, or in some cases, the sex line! He’d say to me, ‘I’ve got terrible trouble with the phone line; can you give it a ring to check’? Thank you; that’s working fine, and another £2 goes straight into the coffers.”
Partly after stricter regulations were introduced on 0898-style phone numbers, the success and the allure of the Full Circle ebbed away until the syndicate eventually ceased to operate. Nevertheless, as Tinkler is keen to stress, Full Circle played a major role in changing the overall landscape of racehorse ownership.

“Times have certainly changed for the better; racing was once known as the sport of kings, but now it’s the sport for all. In 2022, a small share in a horse with Middleham Park Racing can have you standing in the paddock next to Her Majesty the Queen.”
For Tinkler, National Hunt Racing was always his first love, with horses such as The Ellier, Rodeo Star, Bank View, Sacre D’Or and Satin Lover propelling his training career forward at a rapid rate of knots. The Ellier (under Gee Armytage) took the Kim Muir Chase at the 1987 Cheltenham Festival, while a mere six year later, Sacre D’Or plundered the Mildmay of Flete over those same hallowed Prestbury Park fences.
Ironically, in 1991, it was the ill-fated State Jester for whom Tinkler harboured Cheltenham Festival aspirations. After a couple of years of searching for the perfect replacement, Sacre D’Or emerged. Tinkler recalls: “An owner with John Mackie was seeking funds, so Sacre D’Or became available prior to Cheltenham for £22,000. After viewing the horse, my owner said, ‘We’ll offer £20,000’; but I was adamant that for the purposes of luck we should offer the full asking price. When he went on to win the Mildmay of Flete, the first thing I said to my owner was that it’s a good job you gave the full £22,000!”


By the late 1980s, Tinkler was also beginning to make his mark as a flat trainer, even though by his own admission, and despite notching a combined total of nearly 80 winners (1988–89 season), he’d become a little blasé. “Looking back and being self-critical there was no reason to be running horses worth £15,000 in sellers. I’m totally different now, and I’ve never been as dedicated to training as I’ve been over the past few years.”
“I knew two years before I stopped training jumpers that the flat would eventually become my life. The type of horse that I was buying off the flat could only go so far over jumps. They’d win their novice hurdles and then a novice chase or two, but being flat-bred, they weren’t strong enough to sustain multiple seasons over obstacles.”
“To train jumpers, you’d need to aspire to be competing at Ascot, Cheltenham and Newbury, and unless you had £100,000 plus to spend on a single horse, it was very difficult to do that. For not a lot of money, I’ve had runners at Royal Ascot in addition to horses winning at most of the major flat festivals.”
“My horses have a nice, easy life which surprises some people as it’s not like my general attitude. When I’m with horses, a year is like a click of the finger. I’m lucky with loyal owners who basically throw me the rope, and say, ‘Look, just do whatever you think is best.’”
At a sprightly 36, Rodeo Star remains very much the boss of his plush retirement pad at nearby Wetherby. Bought from Sheikh Mohammed at the Newmarket Sales, and with Martin Pipe acting as underbidder, he was knocked down to Tinkler for £26,000. Tinkler speaks fondly of Rodeo Star.
MY HORSES HAVE A NICE, EASY LIFE WHICH SURPRISES SOME PEOPLE AS IT’S NOT LIKE MY GENERAL ATTITUDE.
WHEN I’M WITH HORSES, A YEAR IS LIKE A CLICK OF THE FINGER.”
“He won first time out for us at Newcastle before winning a Tote Gold trophy and a Chester Cup. We took him to Chester on the Monday prior to the race in midweek and worked him around the track under Nicky Carlisle. Immediately afterwards, I said, ‘Right, let’s go and celebrate him winning with a Bucks fizz and champagne breakfast.’ He was a good horse—a very good horse.”
Despite those vividly fond memories, Rodeo Star wasn’t the best horse to pass through Tinkler’s hands at Woodland Stables.

“Sugarfoot was the best horse I’ve ever trained. He won first time out at Ayr as a two-year-old before taking a break. I kicked James Lambie (of the Sporting Life) out of the pub one evening when he had the [audacity] to suggest that the horse must have an injury. I said, ‘He isn’t injured, but he’s our horse and we can do what the f**k we want with him.’
“We backed him each way to win a lot of money (at 40-1) in the 1998 Royal Hunt Cup. He finished fourth under Royston French, but had he been drawn on either side of the track he’d have won that race. He carried 7st 12lb there but was a proper group horse in the making.”


“The next summer he was 107-rated, and with York’s Bradford & Bingley being a 0-105, I rang up the handicapper and said, ‘Look, I’ve got a real problem here. The owner is very unwell (he sadly passed away the following year), and with a real lack of races in which to run, it would help enormously if I could have 2lb back from you in order to race at York.’ I called again from the gallops at 10am the following Tuesday; 105 [rating]. Result: I’d seen him working at home knowing full well that he was a 110-plus horse for the future, and the race at York was ours for the taking!

With none other than Kieran Fallon booked to do the steering that afternoon, [he] gave his seriously ill owner such an immense thrill.”
Tinkler’s training methods have demonstrably stood the test of time, and despite recognising that he’s probably become “a little OCD”, that can only be attributable to a deep passion and enduring admiration for the racehorse.
He eludes, “When Ubettabelieveit went to the Breeders’ Cup, I took him, I rode him, I led him up. When I have a runner at Ascot, I’ll go and walk up with the horse from the stable yard. The other trainers staff know what I’m like, but I do think some of them have respect for what I do.”
“When the press approached me for interview straight after Acklam Express had finished second in Dubai, I said, ‘No, I must go and see the horse first.’ The horses are my best friends.”
As a man who has saddled well over 1,000 career winners, Tinkler acknowledges a certain element of change has occurred with regards the training of racehorses, but his spark and vigor for life continue to be fueled by searching for the highest possible level of performance from each individual horse within his care.
“With training nowadays, the big difference is that you can win a 0-60 handicap with an arm in a sling. When I first started training, you’d have a horse entered for a race a month before, and after he’d run, he’d have a few days break before selecting the next target. You trained every single horse to suit his or her individual needs.”
“Some will state that Martin Pipe revolutionised the training of racehorses, but when the five-day entry system was introduced, most started training their horses on a higher rev-counter. Horses are now usually fit and ready to race but, in my opinion, horses being trained on a higher rev-counter leads to more injuries and therefore a shorter racing career.”
“You can’t have a horse spot on for a race if you make the decision to compete only 48 hours before. It’s like making a Christmas lunch and saying we don’t know whether we’re going to eat on Christmas Eve, Boxing Day or a week later.”
It is testament to Tinkler, that although driven firmly by the strength of his own convictions, he seeks to heap praise upon those to whom he is closest, stating, “I wouldn’t swap my staff.”
“My secretary Samantha (Mark Birch’s daughter) has been with me for 28 years. Helen Warrington has been with me for 22 years. She’s one of the main work riders. My wife Kim—I probably should’ve mentioned her first—rides out four or five lots every single day, and I’d be lost without her.”
“Kim and Helen feed off each other, and I’m just there to pick up the pieces. They train the horses as much as I do. It’s not Nigel—it’s the whole unit.”
Despite such praise, Tinkler is vociferous in expressing his opposition to the recent introduction of joint licences in Britain. “I don’t believe in joint licences, and in any case, I’d have to have the entire team listed as the trainer. How far down the line do you go?”
“If ever you were to get into trouble, how do you penalise or suspend two people? A single-named person must be held accountable. A lot of the time owners don’t like to have horses with people who are older than themselves, so perhaps this is a reason for the greater involvement of the younger generation (i.e., Mark and Charlie Johnston).”
Wife Kim is a qualified jockey coach—a form of mentoring, which had it been available in the early 1980s, Nigel believes it may have prolonged his riding career. Kim is a massive influence behind the scenes at Langton.

“Kim coaches our jockeys, and it’s down to her that our riders have finesse. She not only focuses on their riding style, but also advises on their diet and way of life.”
“Many people think that Kim was lucky because she was small and light, but she was only light because she controlled her diet and exercised properly. At 18, she got to 9st 2lb, but by the time she reached 20, her regular riding weight was 7st. That didn’t happen without a fair bit of effort! She was a dedicated rider (the leading female jockey), and she rode us many, many winners.”
“Jockeys have always had a problem with weight. It hasn’t suddenly become an issue, and it always will be an issue. Wherever you place the line, there’ll be a jockey struggling to make the weight.”
Even in the days when female jockeys were under-represented in the sport, Tinkler recognised added value and was willing to offer competent riders mounts. He explains: “My mother was a jockey; she was leading amateur a couple of times, and I soon realised she had a lot of ability and that horses ran for her. I think the horses like the girls, and some ride a good race and are conscientious.”
Harking right back to the Graham McCourt era, a stable jockey has always been viewed as a necessity to Tinkler. “Graham’s determination to win was simply unbelievable—far exceeds any other jockey that I’ve had riding my horses since. He was so strong that he won on horses that shouldn’t have won.”
Hawick native Rowan Scott, described as being “very chilled”, is the current stable jockey at Langton. Tinkler says, “Rowan is a natural horseman, and it makes no difference to him whether he’s riding in a Gp2 in Dubai or a seller at Redcar. He finds it very easy to ride horses as he’s such a natural.”
Understudy to Scott is the bubbly Lancastrian Faye McManoman, who has flourished with an increased exposure to professional race-riding and the ongoing support offered by jockey coach Kim.

“When a horse comes home after, say, Faye McManoman has ridden them, they’ll usually eat their dinner. Often under more forceful handling, horses can come home and sulk. It’s no problem if a jockey (male or female) is less forceful than a counterpart, so long as there is consistency. The important thing is the horses enjoy their race.”
“When Faye first started riding, she was very moderate. She has worked her socks off to improve. She now rides a good race, and her percentage of winners for the quality of horses she rides is solid.”
“For most races, I’m more than happy for Faye to ride, and the owners love her. In truth, I’m very easy to ride for as long as you try to do it my way. It’s not difficult.”
Tinkler is a hearty advocate of placing a supporting arm around an individual in times of need, but he equally craves strong and rigid leadership from the British Horseracing Authority (BHA). Discussing a recent high-profile disciplinary case, Tinkler says; “To think that a jockey fails a breathalyser test in May, but the case isn’t heard until the following February isn’t good enough for the individual concerned, the other jockeys that are riding or indeed the horses competing in those races.”
“It’s not a greatly expensive job to test riders daily. The BHA are testing a few horses per day on a racecourse, and if a horse is unable to produce a simple urine sample, the costs incurred are significant. Given the amount spent on testing those horses, and without having a go at anyone at all, a jockey who is known to have an issue should be tested daily until the authorities are satisfied those issues have been resolved.”
“It’s basically common sense that we should be testing jockeys more often. Plenty of jockeys have needed support in the past, and plenty will continue to do so in the future, but we can’t have the situation where riders are competing under the influence of alcohol, drugs or whatever.”
ARE EQUAL

















































































































































































































































































































































































“I’d been doing okay training 20 or so winners per year until I got a contact in Hong Kong which resulted in me shifting the emphasis to selling some of the better horses before they’d raced. Obviously, I was doing very nicely out of selling these horses abroad, but some people began to question my skills as a trainer as the total number of winners fell. I addressed that, and the winners have flowed again in recent years. 2021 was my best tally on the flat (41 winners), and as a result, I’ve gained more and more new clients. It’s all snowballed.”
“In 2020, we were lucky to buy Ubettabelieveit because in an ordinary year he’d have gone to the breeze-ups, but given the COVID situation, the vendors were in a difficult spot in that they didn’t know what was going to happen. There were two horses that we liked, and I didn’t know which one to pick, so I rode them both myself and chose Ubettabelieveit, which turned out not to have been a difficult decision!”
“It wasn’t easy for us getting into America to see Ubettabelieveit compete at the Breeders’ Cup. We had to change flights in Atlanta, and the customs officer wouldn’t let me proceed. So I asked Max Pimlott [International Racing Bureau] to pass the papers, which stated I was the trainer.”

He said, “We’re in Atlanta; I don’t think anyone will be bothered about what is happening in Kentucky!”
“During the coronavirus pandemic, you couldn’t simply walk in the United States. I was placed in a room for over an hour while all the paperwork was checked and double-checked.”
“The Breeders’ Cup was a brilliant experience though, and Kentucky is simply out of this world. If you had three or four lives, you’d have one of those in Kentucky.”
With an evident sparkle in his eye, and a glowing smile across his face, Tinkler offers a typically frank and forthright assessment of current stable star Acklam Express: “We knew his three-year-old season would be difficult, so we thought we’d be better off running
during the winter. At his age, we knew that facing the top sprinters would be like banging his head against a brick wall.”
“He did run a good race in the King’s Stand Stakes at Royal Ascot (10th), but we thought, Where are we going to take him next? He needed a little time off to mature, so we took him to Cliff Stud (Helmsley) and turned him out with a view to running in three races at Meydan in early 2022. After that, we’ll certainly think about running him in the United Kingdom during the summer—with the King’s Stand a possible starting point. But we won’t make any firm decisions until the end of April.”
As Tinkler’s playful mind turns to a second or third life somewhere exotic (prior to Kentucky), he also acknowledges the long-standing haven of Malton, North Yorkshire as home away from home. With ambitious local trainers Brian Ellison and Julie Camacho equally instrumental to the ongoing improvements at a shared gallop, and with first-class facilities already on offer at Woodland Stables, the future for any prospective Nigel Tinkler inmate remains rosy.
THE BREEDERS’ CUP WAS A BRILLIANT EXPERIENCE, AND KENTUCKY IS SIMPLY OUT OF THIS WORLD. IF YOU HAD THREE OR FOUR LIVES, YOU’D HAVE ONE OF THOSE IN KENTUCKY.”Ubettabelieveit (centre, red cap) was Nigel’s first runner at the Breeders’ Cup and finished third to Golden Pal in the 2020 Juvenile Turf Sprint.


Equine studies to date have shown that probiotic strains can offer an advantageous approach to minimising disturbances in the gut microbial populations, repair these deficiencies—should they occur—and re-establish the protective role of the healthy gut microbiome. Other probioticassociated health benefits include reducing diet-related diseases such as colic and laminitis, preventing diarrhoea, conferring host resistance to helminth infection, improving stress-related behavioural traits (e.g., locomotion) and even promote the development of an effective gut-brain communication pathway.

Probiotics have been used by humans for more than 5,000 years with their development closely linked to that of dairy products and fermented foods. Today, probiotics are seen as an excellent non-pharmaceutical way to improve the health of both humans and animals, and there are a plethora of products to choose from. But what exactly is a probiotic, and how does it work? Why would your horse need one? What types of probiotics are available for horses? These are all questions that horse trainers ask frequently, which we will attempt to answer here.
Probiotics and the equine microbiome can benefit from a valuable symbiotic relationship; probiotics are seen as a restorative treatment modality for the gut, to re-establish the bacterial populations there and also to re-establish the protective role that the health gut microbiome confers to the host. But when we discuss the equine microbiome, what are we really talking about?
The gut microbiota/microbiome can be categorised by anatomical location such as the oral microbiota/microbiome in the mouth and the intestinal microbiota/microbiome in the intestines, etc. Therefore, the gut microbiome pertains to the microbiota in the gastrointestinal tract. This population of microorganisms (bacteria, fungi, viruses, protozoa) is referred to as the ‘microbiota’ of the gut, while the term ‘gut microbiome’ refers to the genetic material associated with these microorganisms. The microbiome can be defined as the sum of the microbes and their genomic elements in a particular environment. If we look at the definition of the microbiome having the propensity to an equation, then any equation must be balanced; to maintain that balance is key. If the microbial community exists in an environment in a balanced state, then any upset or disturbance to the microbial populations will cause the balance to shift (known as dysbiosis). To maintain the balance, we need to firstly understand the way the microorganisms exist within their community (i.e., their microorganism-to-microorganism interactions and also microorganism-to-environment interactions) and secondly, their functioning role. If we can understand their (microorganism) position and role, then we can maintain the balance or re-establish the balance if a shift occurs.
It is no surprise that the health maintenance of the racehorse is a top priority for trainers. And probiotics can be used as a treatment modality to manipulate the gut microbiome to improve or maintain health.
The human intestinal microbiome is now recognised as an organ and likewise, the equine intestinal microbiome is deemed an ‘organ’ of the body and is vital for the breakdown of complex food and subsequent release of energy, protection against the pathogenic bacterial colonisation and in regulating the immune system and metabolic functions. There has been much debate regarding the content of the healthy equine microbiome, and even to deduce what ‘healthy’ or ‘normal’ is requires a level of understanding of the microbiota associated with healthy horses. This question has been posed by many researchers and frankly has yet to be answered with certainty. There are many reasons why the ‘normal’ microbiota keeps eluding us; and this can be attributed to the many reasons as to why the gut microbiota (of a healthy horse) can be affected (see Fig. 1). It is thought that the diversity of the human gut microbiota and the general assembly of microbial communities within the gut (with the dominant phyla being classed as belonging to Firmicutes and Bacteroidetes) is a shared hypothesis across most species (i.e., humans and animals share a similar gut microbiome structure). Firmicutes and Bacteroidetes have been shown to constitute the main dominant phyla in equine, bovine, canine and feline gut microbiome studies indicating the cruciality of the role they play in the maintenance of a healthy microbial ecology in the gastrointestinal tract. Several studies do agree that dominant phyla of the equine gut microbiota are obligate anaerobes: the gram-positive Firmicutes and the gram-negative Bacteroidetes; other phyla are identified as Proteobacteria, Verrucomicrobia, Actinobacteria, Euryarchaeota, Fibrobacteres and Spirochaetes. Ninety-five percent of the Firmicutes phyla contains the Clostridia genus in addition to genera related to gut health such as Lachnospiraceae, Faecalibacterium and Ruminococcaceae. The other main dominant phyla, Bacteroidetes, on the other hand contains a large variety of the genus.
The role of the gut intestinal microbiota serves to protect and prevent disease. The gut microbiota has several purposes: prevention of pathogen colonisation by competing for nutrients, enrichment and maintenance of the intestinal barrier—their ability to renew gut epithelial cells and repair damage to the mucosal barrier, the breakdown of food and releasing energy and nutrients, such as synthesising vitamins D and K and also conserving and restoration of the immune system by the formation of antimicrobial metabolites and blocking access to the binding sites of the mucosal wall. The gut microbiota is also thought to play some role of influencing the neuro-active pathways that affect behaviour. It is not surprising to see that gut disorders and gastrointestinal diseases can arise when gut dysbiosis occurs. The role of the gut microbiota may have even more importance than is realised and may have a role to play with developing illness or disease later in life.

THE ROLE OF THE GUT INTESTINAL MICROBIOTA SERVES TO PROTECT AND PREVENT DISEASE. THE GUT MICROBIOTA HAS SEVERAL PURPOSES.”



The microbial colonisation of the intestinal tract begins at birth. The foal begins its colonisation through contact with the microbiota of the mare’s vaginal and skin surfaces plus the surrounding environments to which the foal is exposed and reaches a relatively stable population by approximately 60 days in age. It is perhaps a fight for dominance to achieve establishment in the gut among the bacterial populations that sees the foal’s microbiota as being more diverse and quick to change when compared to that of the older horse. The subsequent colonisation of the intestinal tract will reflect the foal’s diet, changing environment, introduction to other animals, ageing and health.
The word probiotic is of Greek origin meaning ‘for life’, and the WHO/FAO have defined probiotics as ‘live microorganisms which when administered in adequate amounts confer a health benefit on the host’. People have long believed that exposure to nonpathogenic microorganisms can benefit the health of humans and animals. The thinking behind this is that daily consumption of sufficient numbers of ‘good’ microorganisms (either bacteria or fungi) can maintain a healthy population of microorganisms in the gut and benefit overall health.
Probiotics are used to manipulate the bacterial populations of the gut in order to re-establish the delicate microbial balance there which, in turn, confers health benefits on the host. As the benefits associated with some of the ‘good’ bacteria within the gut became known, these were referred to as probiotic bacteria.
There are 4 main mechanisms by which probiotics are thought to exert their effects.
1. By inhibiting pathogen colonisation in the gut through the production of antimicrobial metabolites or by competitive exclusion; in other words, they prevent the ‘bad’ bacteria from growing in the gut.
2. By protecting or re-stabilising the commensal gut microbiota, probiotics can be a means to re-establish the balance of the gut microbial populations.
3. By protecting the intestinal epithelial barrier, they maintain the health of the intestinal wall.
4. By inducing an immune response, probiotics can boost the immune system and help prevent disease.
If we consider the definition of a probiotic as ‘live non-pathogenic microorganisms that, when administered in adequate amounts, confer a health benefit on the host’, then this reference to ‘adequate amounts’ must be emphasised, and the dose administered is critical to ensure that the probiotic has the desired effect. For horses, we must consider the route through the digestive tract that the probiotic strains must travel to arrive at their destination
Gut Gold is a Probiotic containing Saccharomyces Cerevisiae and a specifically balanced combination of Mannanoligosaccharide (MOS) and Beta-glucans to help achieve ultimate gut health.

Gut Gold is fully compliant with the rules of racing
NOPS approved.
PEOPLE HAVE LONG BELIEVED THAT EXPOSURE TO NON-PATHOGENIC MICROORGANISMS CAN BENEFIT THE HEALTH OF HUMANS AND ANIMALS.”Beneficial bacteria can be isolated and harvested to prepare a bespoke probiotic.
ELECTROLYTES
The ultimate package of balanced electrolytes and antioxidants to support muscle function and recovery

DIGESTION

Superior quality readily absorbed Omega 3 & 6 to support digestive function, fertility and overall well-being
VITAMINS & MINERALS

Chelated Copper and Zinc paste for optimal absorption to support fertility
FEATURES & BENEFITS
> Specially designed – to manage the loss of electrolytes through sweating

> Sodium – the most important electrolyte as it regulates thirst
• Complemented by potassium, chloride, magnesium and calcium to support whole body function
> Ainseed Flavour – palatable to encourage consumption
> Vitamin C & E – a powerful antioxidant package to aid muscle recovery and maintain a healthy immune system
FEATURES & BENEFITS
> Balanced ratio of Essential Fatty Acids to support:
• Digestive function
• The immune system
• Skin and coat condition
• Fertility
• Joint health
> Fortified with Calcium Hydroxide to improve digestibility
FEATURES & BENEFITS
Chelated Copper & Zinc – in their most bioavailable forms ensuring optimal absorption
> Chelated Copper supports:
• Fertility
• Bone and connective tissue development
• Red blood cell production
• Hoof health
> Chelated Zinc supports:
• The immune system
• Skeletal development
CONTACT OUR SPECIALIST THOROUGHBRED TEAM:
UK: Adam Johnson T: +44 7860 771063
Ire: Lorraine Fradl T: +353 87 2575398
Email: info@foranequine.com
www.foranequine.com
is a distance over 15 metres long. It is a race for survival! The gastrointestinal system has many obstacles along the passage such as the acidic stomach environment and the dangers of exposure to bile and digestive enzymes, in which they must survive. The initial dose of ‘live’ probiotic strains is therefore crucial to ensure survival in the gut. Prebiotics are ingredients such as carbohydrates and fibre, which promote the growth of these probiotic bacterial/ yeast strains in the gut. Prebiotics are essentially the food for the probiotic strains and can help form a symbiotic relationship with the probiotic to improve the overall health status of the horse.

Gut dysbiosis is a fluctuation or disturbance in the population of microorganisms of the gut, which may be linked to a wide range of diseases in horses. Gut dysbiosis can be caused by many factors ranging from dietary changes, antibiotics, disease, intense exercise and training, age, worms, environment, travel, or even minor stress events—resulting in major consequences such as colic. Dysbiosis is generally associated with a reduction in microbial species diversity.
Diet is one of the major factors contributing to gut dysbiosis. Unlike the ruminant cattle and sheep that use foregut fermentation, horses are hindgut fermenters. The large intestine is the main area where fermentation occurs. The horse utilises the microbial enzymes of the hindgut microbial population in the colon and caecum to break down the plant fibres (cellulose fermentation) sourced mainly from grasses and hay. The horse itself does not possess the hydrolytic enzymes that are required to break the bonds of the complex structures of the plant carbohydrates (in the form of celluloses, hemicelluloses, pectins) and starch; so therefore, it strongly relies on the microbiota present to provide those critical enzymes required for digestion. The main phyla Firmicutes and Bacteroidetes possess enzymes capable of breaking down the complex carbohydrates (such as starch and cellulose). Research has shown that forage-based diets (grasses and hay) promote the
most stable gut microbiomes, but ultimately the equine athlete requires far more energy than a forage-based diet can supply. Supplementing the diet with concentrates containing starch such as grain, corn, barley and oats can affect the number and type of bacteria in the gut. Optimising diet composition is so important as carbohydrate overload—as seen with high-starch diets (>1g/kg body weight per meal)—can change the populations of bacteria in the gut, alter pH, upset digestion and the gut environment, and ultimately result in diseases such as colitis, colic and laminitis. The correct diet is essential for maintaining the delicate balance of bacterial populations. Probiotics can be used to either replace the bacteria missing in the gut and/or can help maintain the delicate microbial balance even in the face of adversity such as abrupt dietary changes, antibiotic treatment and stress.
There are several probiotic products on the market, and most are in powder or liquid form. There are two main categories of probiotics: generic and autogenous.
1. Generic probiotics are off-the-shelf products that contain specific strains of bacterial or yeast, singularly or in combination. The Lactobacillus and Bifidobacterium families, Enterococci and yeasts such as Saccharomyces cerevisae and boulardii are the most common equine probiotic strains. Advantages of generic probiotics are that they are widely available, easy to administer, and they may be beneficial to horse health (if the strains are alive in sufficient numbers).
2. Autogenous probiotics are specifically formulated using bacteria obtained from the horse’s own faecal sample and, as such, are uniquely adapted to that individual animal. These host-adapted bacteria are more likely to survive in the gut than non-adapted generic strains and can quickly replenish absent or low levels of bacteria unique to the individual horse, thus maintaining health.
Rachael Blackmore Makes History becoming the first female jockey to win The Gold Cup in 2022 and the First jockey, since 1997, to win the Champion Hurdle and Gold Cup in the same week

THE UNIBET CHAMPION
HURDLE WINNER 2022
HONEYSUCKLE
HONEYSUCKLE FED ON BLUEGRASS RACE HORSE CUBES 15 RUNS, 15 WINS
Bluegrass horse feed powered 23 placings and 6 winners, including winning three out of the four featured races at the Cheltenham Festival



#POWEREDBYBLUEGRASS



“What he probably wouldn’t like people talking about is that he does a lot of good for a lot of people. He’s just not a mé féiner. We should be proud of people like Jim Bolger. What you see is what you get.” –
John Magnier in The Master Of Cool“I liken him to Federico Tesio and that’s the highest praise you can give to anybody. To be able to do what he has done, not just as a trainer but as a breeder and an owner as well – he is a unique man anyway – but to be able to do that in the modern era is remarkable. There’s no one anywhere in the world to have achieved that level of success. He’s a man of strong opinions but he’s also somebody who’s happy to back his judgement. He’s been a great team player for us. There were a few big calls to be made, running New Approach in the Derby, running Dawn Approach in the St James’s Palace after a poor run at Epsom – he’s got courage as well.”
– Joe Osborne in The Irish Field“You know that saying about never making the same mistake twice? Well, I would. I’d always be ready to go back and make the same mistake.” – Jim
Some interesting comments there from three behemoths of the racing and commercial bloodstock world that sum up Jim Bolger and though made in the past, they were emphasised once more in the present, by the exploits of Poetic Flare and Mac Swiney, and by risking the opprobrium of most of his training colleagues and the wider industry in claiming that doping is a serious problem in Ireland.
Coolmore titan, John Magnier referred to Bolger not being a mé féiner, which for our non-Gaelic speakers, is someone motivated only by self-interest. Bolger, he argued, had always had the best interests of the wider industry and people within it, at heart. Also, he was a straight shooter.
Joe Osborne, MD, of Godolphin Ireland, compared the Wexford native, who turned 80 on Christmas Day 2021, to Tesio and it was appropriate. There is no one else in racing now operating at the scale he does as someone who breeds so that he can race in numbers and quality. Unless the landscape of the industry alters significantly, there will never be another.
Osborne spoke too of Bolger’s courage.
Bolger in the Racing PostAnd then there is the espousal by the man himself of the type of philosophy that doesn’t feature in too many self-help books. Don’t be afraid of doubling down if you think you are right, even if first impressions are that the initial call was an error or it went badly wrong on you. That is a testament to his self-belief. Some might call it stubbornness. Call it what you like, we know as a result of what he has built since starting off at Phoenix Park, that it can work – as long as you know what you’re doing.
Galileo, who died last year after a decade of dominance in the stallion stakes, wasn’t even a second thought for breeders until Bolger intervened. Some of that, of course, was necessity. He could not afford to access the commercially popular routes, so had to be creative.
The result was an unprecedented dominance by one stallion but even though he long since has been priced out of sending his mares to the Coolmore record breaker, the proud son of Oylegate was reaping the benefits still in 2021.
Bolger bred and trained Teofilo to an unbeaten champion two-year-old career in 2006 before injury prevented the colt from attempting to translate that brilliance into classic glory.
That success and the Irish Derby victory of Soldier Of Fortune, who also came into the world and was reared at Bolger’s Redmonstown Stud before being sold to Coolmore, rewarded the support of a sire whose first crop had failed to deliver. New Approach emerged from the third crop, out of Bolger’s first Champion Stakes winner Park Express, to be champion two- and three-year-old, emulating his sire to win the Epsom Derby.

Teofilo is the damsire of Mac Swiney, who followed up Gp. 1 success as a juvenile by edging out stablemate Poetic Flare in a thrilling renewal of the Irish 2000 Guineas last summer. Teofilo is also the sire of hugely impressive Ascot Gold Cup victor, Subjectivist, bred by Bolger too. Of course the now Coolcullen resident bred and trained Mac Swiney’s grand dam Speirbhean, and his dam Halla Na Saoire.
It wasn’t just the backing of Galileo that marked Bolger’s outside-the-box thinking. See Mac Swiney’s pedigree for evidence of a lateral approach – the first Gp. 1 winner inbred to Galileo, in this instance, 2x3. It just isn’t the done thing but that wouldn’t ever put the man off.
Last year he sold a Teofilo filly at Goffs who was 2x2 to Galileo and 3x3 to Danehill. To the non-pedigree gurus, that means Galileo is both her paternal and maternal grandsire, while both her grand dams by Danehill. It isn’t that the rule book wasn’t read, it’s just that the bits that didn’t add up to him have been ignored. And the results keep coming.
There would have been no Poetic Flare without that initial support of Galileo either. Again, the Newmarket 2000 Guineas and St James’s Palace Stakes winner’s dam and grand dam, Maria

Lee and Elida, were bred and trained by Bolger, but so was his sire, who had preceded him on both those rolls of honour. Dawn Approach, grandson of Galileo and Park Express, now stands at Bolger’s Redmonstown Stud.
There was a week in October 2020, when Bolger bred four juvenile stakes winners, two of them Gp. 1 winners, and he trained three of them, who ran in the colours of his wife Jackie.
When Poetic Flare prevailed in a ding-dong battle with Master Of The Seas at Newmarket last May, Bolger was the first since John Barnham Day in 1844 to breed, own and train the winner of the mile classic. It would have been eight years earlier only he sold Dawn Approach to Godolphin towards the end of the horse’s juvenile campaign.
25TH
MAY 2022
The Irish Champion Stakes of €1,000,000 over 10f
The Comer Group International Irish St. Leger of €500,000 over 14f
22nd JUNE 2022
The Moyglare Stud Stakes of €400,000 over 7f
The Goffs Vincent O’Brien National Stakes of €400,000 over 7f
The Coolmore America ‘Justify’ Matron Stakes of €400,000 over 8f

The Flying Five Stakes of €400,000 over 5f
FOR MORE INFORMATION VISIT irishchampionsweekend.ie
That places context on his training and breeding feats in 2021. That his 54-year-old son-in-law Kevin Manning was still in the plate, as strong as an ox in Newmarket, cool as a breeze at Royal Ascot was surely the cherry on top of the cream. They have shared glory all over the world together. The trainer isn’t the only one of them for whom age is no barrier to attacking a day and any challenge that comes with it, with vigour.
Courage, conviction and he would argue, a sense of fair play for all, were behind his decision to speak out about his suspicion that doping is a major problem in Irish racing, initially in an interview in The Irish Field at the time of his spectacular breeding success in October 2020.
He discussed the issue in greater depth in interviews with Paul Kimmage in the Sunday Independent and in other interviews, in print and podcast, though some demanded more detail.
While there was some support from trainers, most notably Ger Lyons, Johnny Murtagh and Richard O’Brien, and a handful more that expressed such support below the radar, by and large, his peers were outraged.

He decided not to accept an invitation to appear before the Joint Oireachtas Committee to look into the claims. That was prudent legally and while the Twitterati scream for names, you can know things and not be able to prove them. That failure to show or offer hard evidence has been interpreted by the majority within racing as meaning he has nothing and is engaging merely in “pub talk”, as Aidan O’Brien, his former assistant put it. The leadership of the Irish Racehorse Trainers’ Association, of which he is no longer a member, was more scathing.
The raid on a stud farm just outside Monasterevin is concerning however, though details remain sketchy, not least surrounding the identity of substances confiscated from John Warwick.
Bolger would be pleased with a conversation that began, with media outlets outside of the Irish Horseracing Regulatory body taking interest, with considerable dope-testing being beefed up— which was once moot. He’d also be pleased with the IHRB now
facing inevitable changes of governance and structure as a result of recommendations for the Joint Oireachtas Committee.
But if there is doping, the cheats need to be rooted out. And if there isn’t, the system needs to be robust enough to ensure that there is confidence in this being the case. But Lance Armstrong passed 500 tests. Most forms of enforcement are reactive—the cheats, the criminals lead the way.
That’s where retrospective testing comes in and given the samples are kept, one hopes that this might happen. It is all for the benefit of the sport and business in the end. Bad publicity that might come from unearthing cheating is something to be proud of because it is something you can stand by. As Murtagh said, “The guns are out… This will be good for Irish racing.”
Prior to the Irish Champion Stakes, Bolger told Johnny Ward, of this parish, in an interview in The 42 that what marked Poetic Flare out was talent and robustness. “I’ve trained nothing as hardy as him.”
Fashioned in his maker’s image, it seems. Completely durable. Suffice to say, in his four score years, the boss of Glebe House and Redmonstown Stud has left his mark and continues to do so.
This article was first published in the Irish Racing Yearbook 2022, for more information please visit www.irishracingyearbook.com or scan the QR code below

Tuesday 14th - Saturday 18th June 2022
TUESDAY, 26TH APRIL 2022
Situated in the outskirts of the capital Oslo, Øvrevoll is the only racecourse in Norway. This season, we hope you will consider our pattern races for your horses. We wish to welcome owners and trainers to experience Norwegian horse racing and hospitality on our biggest race day.
Sunday August 21st, to close on June 20th
THE MARIT SVEAAS MINNELOP (Group 3) 1800 meters (1m1f), total value NOK 1.200.000 (€ 119.760)
THE POLAR CUP (Listed) 1370 meters (6f185y), total value NOK 500.000 (€ 47.801)
LANWADES STUD STAKES (Listed). For fillies and mares, 1600 meters (1 m), total value NOK 300.000 (€ 28.681)
THE QUEEN ANNE STAKES (1m) STRAIGHT | £600,000
THE KING’S STAND STAKES (5f ) | £500,000
THE ST JAMES’S PALACE STAKES (1m) ROUND | £500,000
THE PRINCE OF WALES’S STAKES (1m 2f ) | £1,000,000
THE GOLD CUP (2m 4f ) | £500,000
THE COMMONWEALTH CUP (6f ) | £500,000
THE CORONATION STAKES (1m) ROUND | £500,000
THE PLATINUM JUBILEE STAKES (6f ) | £1,000,000
For further information contact: Chris Stickels, Head of Racing and Clerk of the Course, +44 (0)7970 621440 Adrian Beaumont, IRB, adrian@irbracing.com, +44 (0) 7808 903 158
For each horse trained outside Scandinavia participating in Group races, travel allowances will be subject to agreements.


Please note that jockeys are not allowed to carry a whip in races for 3-years old and upwards.
For further information, please contact Liv Kristiansen: liv.kristiansen@rikstoto.no
International Racing Bureau Newmarket, UK + 44 1638 66 8881 Max Pimlott: max@irbracing.com




Ask anyone to list five famous Belgians, and odds are that Kevin De Bruyne’s name will make an appearance.
The Manchester City midfielder is widely regarded as one of the best footballers of his generation. Yet you might not have heard of him at all were it not for an innovative talent development scheme in his home country that could influence the way we select, train and manage racehorses.
Traditionally young footballers, like racehorses, are grouped age. By contrast, bio banding is the process of grouping athletes on the basis of attributes associated with growth and maturation, rather than chronological age. “Whether you mature earlier or later has quite a lot of bearing in sport, where greater speed, strength or power can be important,” explains Professor Sean Cumming, an affable Orkney Islander based at the University of Bath who studies growth and maturation. “When you look at children in sport, we group them by age for competition and for training. And while age groups are great in so far as it allows you to match kids of similar cognitive development, motor skills and experience, the challenge is that kids can vary hugely in
terms of their biological maturity.” Although the effect of this ‘maturity bias’ doesn’t kick in until pubertal onset at around 11 or 12 years of age, the variance in biological maturity can already be anything up to five or six years by that point.
The concept that relative age can play a determinative role in future sporting success is not new. It explains why broodmares are covered in spring to produce foals in February and March. A winter-born colt running in the Derby in early June of its three-year-old year may be up to 10% of its life older than a spring-born animal— an unquestionable advantage. Or is it?
Indeed, it’s not only in horse racing where the orthodoxy around the so-called ‘relative age effect’ holds sway. In his book Outliers, Malcolm Gladwell notes that a disproportionate number of elite Canadian hockey players are born in the earlier months of the calendar year.
The reason, he posits, is that since youth hockey leagues determine eligibility by calendar year, children born in January are pitted against those born in December. Because the earlier-born children are likely to be larger than those born later (at least until somatic factors kick in), they are often identified as better athletes.
This, in turn, gives them more exposure to better coaching, and the gap between the two groups widens. Sociologist Robert K. Merton has dubbed this the ‘Matthew Effect’ after a verse in the Gospel of Matthew: “For unto everyone that hath shall be given, and he shall have abundance. But from him, that hath not shall be taken away even that which he hath.”
But, cautions Professor Cumming, this only tells part of the story: “What even a lot of the academics get wrong is that relative age and maturity are not one and the same. In fact, our data shows that only about 8% of the relative age effect in academy football can be explained by physical maturity. It’s quite possible to be the oldest kid in the age group but also the least mature, or the youngest kid in the age group but also the most mature.”
The focus on relative size and strength alone, in other words, can create a bandwagon effect. “If you’re looking to identify and develop the most talented young athletes, then it’s going to cloud your vision. It’s going to make some kids look fantastic and some kids look quite poor.” Perhaps tellingly, the last January-born Derby winner, Pour Moi, came in 2008. The youngest winner of the last 10 years, Anthony Van Dyck, was born in mid-May.

Enter De Bruyne. The Royal Belgian Football Association’s Programme of the Futures, as it is known, allows late-developing players to hone their skills by playing mostly friendly matches against teams of the same physical maturity level, irrespective of age. De Bruyne is the scheme’s most famous graduate. Other members of the late-developer club include Dries Mertens, Thomas Meunier and Yannick Carrasco. By deliberately creating a climate in which late-maturing players get a second bite at the cherry, a country with a population of just 11 million has become a global footballing superpower. Unsurprisingly, other nations are starting to catch on, and several similar programmes have sprung up across the UK and Europe.
Every professional football club has a story about the one who got away—the player that was cut from their programme for being too physically small, from Jamie Vardy (released by Sheffield Wednesday at 15) to Harry Kane (the now 6’2” striker

was released by Arsenal at the age of nine). But the consequences are more far-reaching than just missing out on the next footballer superstar. There is compelling evidence to suggest that tailoring the training load to the stage of the athlete’s biological maturity can reduce injuries. The amount of time spent off through injury during an athlete’s formative years is thought to be one of the single biggest factors that determines future professional success. Since overuse injuries and stress fractures all peak when the athlete is going through their pubertal growth spurt, it is important to identify when an athlete is entering this phase and adjust the load accordingly. As Professor Cumming explains, “Because we know the growth spurt typically takes off at around 85-86% [of the athlete’s predicted adult height] and peaks at around 90-91%, as soon as they move into that phase we can change the training prescription to more developmentally focused stuff—coordination, balance, core strength—all things that are going to help the child transition to a phase when their body is changing rapidly, when they’re more at risk of certain types of injuries.” Early evidence from clubs using the method has pointed to a 72% reduction in injuries.
And it’s not just football clubs that are starting to understand the benefits of bio-banding. Daniel and Claire Kübler have been bio-banding their horses using knee x-rays, among other metrics, to determine when to increase a horse’s workload. “We back most of our own horses and train them away to where they can canter relatively comfortably at a normal speed,” says Daniel. “Once a horse can canter away, that’s when we go in and do that first set of x-rays.” The horses are given a grade based on the degree of fusion in the growth plates in the knee, with A being an open growth plate, B being partially closed and C being a closed growth

plate. “Those really open ‘A’ horses, you might say, ‘OK, there’s no point—give it a break,’” says Daniel. The C’s, likewise, tend to be easy cases. “It’s really the B horses that are the interesting ones, where you have to make a bit more of a decision,” says Daniel. “What we don’t want to be doing is increasing the workload on a horse that’s relatively immature.”
Although the growth rate in horses varies somewhat by breed, most horses do not reach full physical maturity until around six years of age, with larger breeds like draft horses still growing until eight years of age. A two-year-old horse is an adolescent; it has reached approximately 97% of its mature height by 22 months but critically, its bones will not fully fuse for another four years.

Like humans, horses grow distal to proximal—that is, from the feet up—with the pasterns developing first, fusing at around six months, followed by the cannons at around the one-year mark. The pelvis and spine fuse last. It is during the horse’s two-yearold year that the major leg bones—the radius, ulna and tibia— will fuse. It is therefore important to understand when a horse is entering its growth spurt and tailor its regime accordingly. “It’s about injury reduction,” argues Daniel. “Young athletes are highly susceptible to injury, and by recognising and identifying the growth spurt, you’re massively reducing the injury rate by adapting the training load.”
“The knees are the most delicate bit,” he goes on. “That’s where most of your injuries occur that can cause problems down the line. When you’ve got one with poor grading on its knees, it’s being pre-emptive in your training,” he continues. “You would train that horse a bit more conservatively and not push it quite as hard. You might spend more time on an incline gallop, or you might introduce swimming into the horse’s routine so that you’re putting a bit less concussion through those joints. And hopefully you’re getting the benefit down the line, because they haven’t been pushed too hard, too young.”
Joint licence-holders Daniel and Claire have long advocated for the role of science in training racehorses. “We’re not scared of it,” says Claire, who holds a degree in physiology from Cambridge University. “Having the additional awareness of it gives you a greater understanding,” she asserts. Coming from a nonracing background, meanwhile, has allowed Daniel to approach training with something of a fresh perspective: “It’s the critical questioning. A lot of things in racing are done because that’s the way they’ve always been done, and you can work backwards and find that the reason they work is because, scientifically, it stacks up. But there’s other things where you actually go and look at the science, and it doesn’t make any sense to do that.”
“I love reading about human sports science and listening to podcasts to get ideas,” he explains. “Essentially we’re all mammals, and although there are some differences, there are also a lot of similarities.”
Following the science has not only allowed the Küblers to produce happy, healthy horses—“I’d like to say our horses are very sound and durable,” notes Claire—it has helped them manage owners’ expectations. “Owners enjoy the insights and better understanding themselves as to how the horses progress and develop,” she says.

IT’S ABOUT INJURY REDUCTION. YOUNG ATHLETES ARE HIGHLY SUSCEPTIBLE TO INJURY, AND BY RECOGNISING AND IDENTIFYING THE GROWTH SPURT, YOU’RE MASSIVELY REDUCING THE INJURY RATE BY ADAPTING THE TRAINING LOAD.”
DANIEL KÜBLER






































































- William Haggas
“As a trainer, sometimes you can look at a horse and you can see it’s backwards and it needs time,” says Daniel. “What’s helpful about having the knee x-rays is that it’s a very visible thing to show to someone who doesn’t necessarily understand horses particularly well or isn’t used to them. It’s a simple way to say, ‘Your horse is immature.’ That’s a helpful tool as a trainer in terms of being able to communicate very clearly with your owners.” Posting regularly on social media, meanwhile, has attracted interest from outside the sport—including from Professor Cumming himself, who reached out to Daniel through Twitter.
The science is certainly compelling. But, emphasises Daniel, you cannot rely on data alone. “You can’t solve the challenge of training racehorses purely with numbers in the same way that I don’t think you can solve it purely just by looking anymore, because you’re not looking at bits of information. It’s an example of using a scientific, data-driven, analytical approach to enhance the welfare and time the horse’s development in the right way for that individual,” he says.
“The numbers don’t lie, but still you need the horsemanship,” agrees Claire. Feedback from the work riders, she says, can provide as much insight into a horse’s state of growth as an x-ray. “They can pick up on the horse, whether it’s still maturing and doesn’t quite mentally understand what it’s doing. Then you can come up with ideas together as a team,” she says.
In a climate where racing, and equestrian sport in general, is the subject of increasing scrutiny—both from outside the sport and from within—it is submitted that any sports science techniques that can deliver tangible welfare benefits to the horse should be embraced.




“At the end of the day, they have to go out and race, and they all have to be sound enough to do that,” says Daniel.


“You’re always trying to find ways to help get an edge on the track—to get more winners,” agrees Claire. “But you also just want to do the best for the horse so you’re getting a sound horse to achieve its optimum best.”
Feedback from work riders is just as important as the science and can provide as much insight into a horse’s state of growth as an x-ray.





I’D LIKE TO SAY OUR HORSES ARE VERY SOUND AND DURABLE.OWNERS ENJOY THE INSIGHTS AND BETTER UNDERSTANDING THEMSELVES AS TO HOW THE HORSES PROGRESS AND DEVELOP.”
CLAIRE KÜBLER

New Pursuit, trained by Kevin Philippart De Foy winning the British Stallion Studs EBF Restricted Maiden Stakes at Epsom.


“Since day one my whole yard has been fed on Spillers Horse Feeds. I couldn’t be happier with the horses’ condition and really feel that the feed supports their health and performance. I particularly like the Ulca Power Cubes and their benefit to the digestive system”






- Kevin Philippart De Foy
©Mars, 2022. www.spillers-feeds.com
How often have you heard that a horse is bred to race a certain distance? That may be accurate, but sometimes stride length and frequency say otherwise.



During her 2yo season, she raced over 1100m (5.5f) and ran well
During her 3yo season, she didn’t show any progress even though she showed good fitness abilities during training

By quantifying a horse’s stride frequency, one may possibly determine the race distance over which the horse performs best. To assess Madam Arionea’s stride abilities, we shall examine her stride frequency and length at a speed of 60 km/h rather than at top speed. This enables us to make appropriate comparisons.

Because her stride frequency does not enable her to compete with horses with the profile of a Sprinter, Madam Arionea would be better placed in a race distance slightly longer than 1100m (5.5f).
Given her locomotion data, the trainers decided to progressively increase her racing distance and start her over 1300 / 1400m (6.5f / 7f).
The mare’s locomotion may have changed once she gained strength and endurance. Her stride length grew while her stride frequency decreased. As a result, for her to perform successfully, her racing distance had to be increased to provide her time to accelerate, as she use her stride length to reach her top speed.
One of the primary goals of athletic trainer is to establish a suitably high workload to develop the desired qualities, while controlling the amount of exhaustion caused by the training. Indeed, an excessive amount of fatigue might lead to the threshold associated with injury. Therefore, measuring a horse’s training helps to develop competitiveness while respecting the physical and mental integrity of the horse athletes.
How to adapt an undertrained racehorse’s training?


An undertrained horse has never been trained with a workload for what is required during a race and his body would be unable to keep up with the effort.

CONCRETE EXAMPLE

Bad blood results, then training paused to recover
Visually good comeback to training, but fitness not as good as pre Gr.1 win
Based on the statistics shown on the right, Monsieur Arion’s recovery ability has worsened slightly for the same degree of training: his heart rate after exercise is 166 BPM, up from 114 BPM when he raced in October. This is also true for his recovery 5 minutes after the effort ends.

The trainer was also able to evaluate the differing fitness data to explain the performance loss. By interviewing Monsieur Arion’s prior trainer, he was able to confirm that his training intensity had decreased because of their different training approaches. He decided to increase the training workload by increasing the distance and intensity.

WITH THIS METHOD, MONSIEUR ARION’S FITNESS IMPROVED AND IT LED TO ANOTHER GR.1 VICTORY.Group 1 winner, we will call him Monsieur Arion


We all want what’s best for our horse and we are happy to pay a price for the benefit of a happy, healthy and peak-performing horse. But what if that price is a hefty fine, suspension or even serious health consequences for us and our staff? How much trust can we afford to place in the claims of manufacturers, and do we pay enough attention to instructions?
Ultimately, the responsibility for what goes into our horses lies fully with us. In this article, we’ll focus on the nutritional product labelling as well regulation of products which are promoted to consumers.
Dr Corinne Hills is an equine veterinarian with more than 20 years’ experience in practice in Canada, the Middle East, Europe, New Zealand and Australia, leading her to develop Pro-Dosa BOOST, manufactured from her own purpose-built, GMPregistered laboratory in New Zealand.
“We all want to make good choices and support our horses in the best way we can, with the best use of our finances,” Dr Hills agrees. “Horsemen always ask me about ingredients, but nobody ever asks about quality management. Similar products might appear to contain the same ingredients, but if the quality of the ingredients is poor, they will provide no benefit. Think about what you are spending your money on, and learn to read labels critically.
“It’s important to know the nutrient content of your feed and forage. In a perfect world everyone would consult their nutritionist and have forage tested, knowing exactly what their horse requires, what it is receiving and what supplements, if any, are needed. Horsemen don’t always feed a ready-prepared
balanced feed. If they are mixing their own, they should be analysing the components of their feed. It’s easy and inexpensive, and your vet will know where you can send samples for analysis. Good feed companies provide the service for free.

“Simply reading the label of feed and supplements could save you quite a bit of money. In my experience most people way over-supplement. A balanced feed manufactured by a reputable company should provide all of a horse’s requirements. Adding supplements could disturb the balance of the nutrients being fed. It is worth taking the time to understand nutrition to effectively support equine health. You can go to your feed company and ask their in-house nutritionist to suggest a tailored balanced diet that will suit most horses in your stable. If the feed company doesn’t have a nutritionist, it might be worth looking around for a new feed supply.
“Metabolism is quite complex, requiring a broad range of essential nutrients to function optimally. A lot of one nutrient doesn’t make up for deficiencies in another. The balance between nutrients is important. Some nutrients are required for the uptake and function of other nutrients. Too much or too little of one nutrient may result in deficiencies or toxicities of other nutrients. Imbalances can adversely affect health, performance and recovery. At a minimum, imbalances in a feed or supplement can render a product ineffective.
“For instance, vitamin C is required for the absorption of iron from the gut. Without vitamin C, iron passes straight through the gut and out in the faeces. Vitamin E, on the other hand, has a negative interaction with iron. It binds with iron and reduces its absorption, causing much of it to be wasted. So, in order for horses to use dietary iron effectively, it must be administered with vitamin C and without vitamin E. Iron balance is also closely related to zinc, manganese, cobalt, and copper.”
“B vitamins are known to work better when administered in optimal balance with each other. Amino acids are another good example of how nutrient balance is important. The balance of amino acids in a feed is as important as the amount of protein. Imbalances in amino acids limit the amount of protein in a feed that is usable in the horse to produce proteins and muscle cells, and the wasted amino acids that can’t be used for protein synthesis create a load on kidneys, elevate body temperature and elevate heart rates.
“It is also important to adhere to the instructions on the label. If insufficient doses are given, then no impact or a negative impact on the overall health of horses may result.
“If you are buying a supplement that doesn’t contain what the label says, then at best, it’s a waste of money. At worst, it could be detrimental to your horses’ health. Giving too much of some nutrients is dangerous.”
Reading the label isn’t always an easy fix, however, as Dr Hills points out.
“Standing in a feed store, I couldn’t easily choose a good one as I couldn’t work out what was in each one by just looking at the labels. I had to photograph the labels and then put the information into a spreadsheet, convert all the quantities and units to a single standard, and then compare those contents to equine nutrient requirements.
“How many horsemen do that? And if they don’t know what they are feeding their horses, aren’t they worried?”
Dr Hills has one simple tip. “If labels are easy to understand so that you can tell at a glance what you are giving your horse, then the manufacturer is probably proud of their formulation and believe it will stand up to scrutiny.
“If you have to perform too many calculations to figure out what you are giving, there is a fair chance that the formulation isn’t great. Some companies don’t actually want you to know how much or little of each nutrient is in their product. Take the time to do the maths and make sure you are making a true comparison before picking the cheapest or prettiest product on the shelf.
“When reading labels, it is important to consider all aspects of the nutrient composition—including balance, form and dose—in relation to the nutrient requirements of your horse.
“I found a huge number of products listing different combinations of nutrients that were included in different forms. For example, calcium could be provided as calcium carbonate, tricalcium phosphate, or calcium gluconate. They were also quantified with different units of measure, such as mg/kg, %, ppm, to name only a few. Then, they were to be given in different doses.
“The most confusing paste I found listed contents in terms of parts per million (ppm), percentages, and mg/kg. Then, the syringe was in pounds and the recommended dose in ounces.”

“Be sure to ask every rep that visits your stable about quality management as they will almost certainly be the most readily available source for this information. Any rep that can’t talk competently about their company’s quality management programme probably represents a company that doesn’t have one.
“GMP stands for Good Manufacturing Practice, and this is a specific standard required for pharmaceutical producers. It is, however, voluntary for feed supplement manufacturers. A generic version of good manufacturing practice, abbreviated with small “gmp,” is a reference to a quality management system that is not government specified and inspected. It could be the same as GMP or it could be applied to a non-standardised or less complete quality system.
“If a company has either ISO or GMP certification, you can be sure that the supplements they produce will be safe, secure and generally meet label claims.
“Once you have selected a good quality, safe and healthy feed, then you can probably feed it to most of the horses at your stable. Spelling horses and smaller horses will need to eat less of it with more hay or grass. Racehorses or broodmares will need to eat more of it.”
The Veterinary Medicines Directorate (VMD) is the regulator of veterinary medicines in the UK. Louise Vodden and James Freer, from the Enforcement Department of the VMD, guide us through the draft documentation outlining the legislation behind the manufacture, sale and labelling of equine health and welfare products.
When advertising a non-medicinal veterinary product, it must not, by presentation or claims, suggest that it is medicinal.
This applies to any advert—be it in magazines, online, at trade events or through client meetings and listing materials—that is aimed in part or in full at a UK audience. It is the responsibility of anyone engaged in marketing activities to comply with the VMD.
A veterinary medicinal product is legally defined as:
• Any substance or combination of substances presented as having properties for treating or preventing disease in animals.
• Any substance or combination of substances that may be used in, or administered to, animals with a view either to restoring, correcting or modifying physiological functions by exerting a pharmacological, immunological or metabolic action, or to making a medical diagnosis.
The first part of the definition above covers products that indicate they have a beneficial effect on an animal’s state of health. This is known as “medicinal by presentation”.
• Prevention This includes the destruction of parasitic infestations on an animal that may cause a medical condition, such as flea allergic dermatitis; hence, products that kill fleas on an animal are also classified as medicines.
• Disease This is considered to cover a broad range of conditions ranging from those caused by bacterial, viral or parasitic infections, to disorders resulting from various systemic dysfunctions, or deficiencies of substances essential for survival. We generally use the catch-all term “adverse health condition” for something wrong with an animal’s state of health. This includes injuries that pose a significant risk to wellbeing or would require more than the most superficial of management.
The second part of the definition covers two further aspects. The first relates to products containing substances with a recognised medicinal effect, commonly referred to as “medicinal by function”. The second covers the purpose of putting something in, or on, an animal to effect a change (restoring, correcting, modifying) in the way a bodily system works.
• Restoring This covers claims of restoration of function in any system within an animal that, for any reason, is not functioning within the normal range for an animal of good health. Even if there
is no claim, be careful not to present before and after treatment expectations in your advert. For example, in one picture the dog can barely walk, and in another the same dog scampering along apparently healed. Such an advert would be considered medicinal by presentation.
• Correcting This covers any product used to address any deficiency or dysfunction in an animal’s systems. This includes issues like nutritional deficiencies in an animal, hormone imbalances, immunomodulation to address allergic reactions and correction of digestive dysfunction.
• Modification This includes any effect that changes the way an animal functions that is not covered by restoration or correction effects. In most cases, these tend to be enhancement claims such as “boosting”, “better”, “stronger”. Where such claims are made, the immediate question is, “better than what?” If the answer is, “better than normal,” then the product is considered medicinal by presentation. If the answer is, “better than an animal with condition X,” then it is considered as claiming to be medicinal by function.
Non-medicinal products cannot claim to treat, prevent or control any adverse health condition. Nor can it refer, expressed or implied, to the treatment or prevention of a disease or adverse condition, or to improving the state of health of the animal treated.
For example, medicinal claims include a reference to the treatment or prevention of scours, colic, footrot, laminitis, sweet itch or pathological nervous conditions—or any other condition which is not the normal state of a healthy animal. This includes references to symptoms or any indication that the product is for use in an animal which is not in a normal healthy state.

References to the nutritional maintenance of a healthy animal, healthy digestive system or healthy respiratory system would not normally be regarded as medicinal claims. Though this does not extend to claims for preventing the occurrence of an adverse health condition or its symptoms.
Any implication that the product for use in an unhealthy animal and is intended for purpose of, or has the consequential outcome of, preventing a detrimental health state in an animal would predispose the product for a medicinal purpose for which it would require a marketing authorisation. Exceptions to this include particular nutritional purpose feeds, however, there are also specific restrictions on the claims these products can make.



“Whoshotthesherrif looks tremendous having been in training since July. He continues to look and perform to his highest level with a great topline. This was a very satisfying second win of the season off top weight.” Phil Kirby
The basic premise is that the purchaser of the product has a healthy animal and will be using it to support their animal’s state of health. Health maintenance does not include attempting to halt or slow the progression of a detrimental health state.
• Association with an adverse health condition
Narratives may not be used to suggest some terrible disease will or may happen, nor using statements like “4 out of 5 get” to present the product as the solution. This is considered a medicinal claim. Occasionally this approach is prefaced with the overtly medicinal company statement of intent that “we believe prevention is better than cure”.
Reference to specific diseases may be made in the form of a safety warning where use of the product may pose a risk, for example “WARNING: Not to be fed to horses with PPID”.

A product not authorised as a veterinary medicine must never be presented, in any capacity, in comparison to any form of authorised medication. Marketing material for a non-medicinal product must not indicate or imply that the product can, or is intended to, be used as a substitute for authorised veterinary medicines. Nor should the use of a non-medicinal product be presented as resulting in the reduction of the use of any authorised medication. To do so is considered a medicinal claim for the product.
Disclaimers do not provide a remedy to the misrepresentation of a product in a medicinal capacity.
If customer testimonials are used in connection with the marketing of a product and report results containing medicinal claims, the claims will be regarded as those of the company marketing the product.
Claims made by a third party, such as magazine reviews or articles published by independent analysts, will be regarded as those of the company marketing the product where evidence confirms that the third party has a connection to the marketing company via solicitation, endorsement, sponsorship or funding.
If, for example, a vet who has been using a product for years expresses an opinion that is not being given in support of marketing a product, then it would just be an opinion. Any material published in support of marketing the product is considered to be marketing material. Whether that material is based on professional opinion, peer review studies, customer feedback, folkloric tradition or an “everybody knows”claim is not relevant. It must still adhere to the rules governing marketing material.
Herbal products, “nutraceuticals”, or any products sourced in a way generally described as “natural” are treated like any other products. A natural origin provides no exemption from these requirements; they require authorisation if they are medicinal by function or presentation.

The following are always medicinal products requiring a marketing authorisation due to their use on animals:
• Veterinary product that contains substances that kill insects or external parasites (e.g., pyrethrins, pyrethroids or organophosphate compounds) as they are medicinal by function
• Veterinary product claiming to have, or which has, the function and control of internal parasites
• Veterinary product claiming to treat or prevent a disease caused by a viral, bacterial or fungal infection
The following do not require an authorisation, provided they do not claim to treat or prevent disease:
• Product containing a repellent, such as diethyltoluamide or ethylhexanediol, provided it claims only to repel external insects
• Product applied only to housing or bedding
• Topical disinfectant applied to intact skin provided it does not claim to treat or prevent disease, including infection prevention (e.g., shampoos)
The marketing of these products is covered by legislation on biocides.
For further information regarding non-medicinal products, email: enforcement@vmd.gov.uk or call: +44 (0) 1932 338308 or +44 (0) 1932 338410.







WHY IS FRANCE BECOMING THE FASHIONABLE PLACE TO TRAIN?

The French racing industry has always attracted an international profile of professionals and continues more than ever to do so in the 21st century. The Qatar Prix de l’Arc de Triomphe was once again crowned Longines World’s Best Horse Race for its most recent edition, and the very sport of horse racing as we know it was brought to the country by an English lord two centuries ago.
Indeed Chantilly’s destiny as the headquarters of French racing was shaped in the 1800s by the arrival of British training families such as the Carters, Cunningtons and Jennings.
Brothers Tom and Henry Jennings still hold the record for the number of wins in the Chantilly Classics with respectively 10 Jockey-Club successes for the former and nine Diane victories for the latter, whose family tree descends directly to Alec Head and his offspring Criquette and Freddy.
While the Head family is now firmly ‘tricolore’, British influences continued until recently in Chantilly with Gp. 1 trainers such as Jonathan Pease, Richard Gibson and John Hammond. It is interesting to note that the only British-born trainer currently
active in Chantilly is Andrew Hollinshead, although top jumps jockey James Reveley has purchased a yard in the town and declared his intention to train there once he retires from riding.
Today, with the best prize money in Europe and top-class facilities, France has become a destination for trainers from all corners of the globe; and in Chantilly alone, the profession’s ranks span five continents and fifteen nationalities.
Close neighbours Spain, Italy, Germany and Belgium are represented by a number of professionals such as Carlos Laffon-Parias, Mauricio Delcher-Sanchez, former professional footballer Markus Munch and Andreas Schutz who chose the location at the end of his stint in Hong Kong. Other Europeans include recent Greek arrivals Giorgios Alimpinisis and Attilio Giorgi, and Scandinavian couple Pia and Joakim Brandt. The young and ambitious Irish pair Gavin Hernon and Tim Donworth have both chosen Chantilly to launch their respective careers, and the American continents are represented by former International Herald Tribune journalist-turned-trainer Gina Rarick and young Argentine handler Sebastian Caceres. Add to the mix Japanese duo Satoshi Kobayashi and Hiroo Shimizu, plus Tunisian Hedi Ghabri, and it must be near impossible to find a more cosmopolitan racing centre.

After generations of domination in Italy, the Botti dynasty spread to Newmarket with Marco in 2006, and two years later his cousin Alessandro set out in Chantilly, initially as assistant, then in a joint licence with father Guiseppe.


The popular Italian was all smiles after saddling a quickfire double in the opening two contests on a Chantilly all-weather card in February, in the process pocketing €32,720 in prize money and owners’ premiums. He remembers, “I spent time with my cousin in Newmarket before deciding to come here. I didn’t speak a word of French, but we thought it would be a good idea to have a Botti presence in France! To start with, everything was complicated. We were a Classic stable in Italy, but it wasn’t easy to adapt to the right level of horses, the organisation and of course the language. One of our staff members spoke French, so in the early stages he helped a lot with translating; but I had to learn French to take my trainers exams. I’m perfectly at home here now and after all, France is quite similar to Italy!”
From a racing point of view, the prize money and prestige are in contrast to the current situation in Italy and crucial for attracting owners, which for Botti include some of football’s biggest stars such as Champions League winning manager Carlo Ancelotti and top striker Javier Pastore. “I’ve had connections with the football world for a long time as the racehorse training centre at Milan is next to the stadium, but it’s much easier to attract footballers to racing in France where they find the whole package more exciting. Carlo Ancelotti has been an owner with us for 10 years, and now the challenge is to find him a horse to be as successful in racing as he has been in!”
Another well-established European in Chantilly is Pia Brandt, who now operates as a joint licence holder with husband Joakim. Pia, who has won a pair of Gp. 1 victories in her adopted homeland (Grand Prix de Paris with Mont Ormel and Criterium de Saint Cloud with Mkfancy), remembers, “I came here at the end of 2005 because I wanted the best. An owner was supporting my move, and I could have picked any location in Europe. I chose Chantilly for the quality of the training facilities, the proximity to the airport, and of course the French prize money. I already spoke some French as I had spent time riding out here when I was younger, and the father of my son is French.” Pia says. “However my French wasn’t very academic, and I remember that utilities companies
I SPENT TIME WITH MY COUSIN IN NEWMARKET BEFORE DECIDING TO COME HERE. I DIDN’T SPEAK A WORD OF FRENCH, BUT WE THOUGHT IT WOULD BE A GOOD IDEA TO HAVE A BOTTI PRESENCE IN FRANCE!”
ALESSANDRO BOTTIThe Qatar Prix de l’Arc de Triomphe, held at ParisLongchamp was once again crowned the 2021 Longines World’s Best Horse Race.
would often hang up on me when I asked if it was possible to speak in English! I think that things have improved in that aspect since then, and English is spoken more here now. At the time, the rules were that if you had had a licence for five years in another country in Europe, you didn’t have to take the trainers exam here, so I just had to follow a few modules at the racing school.”
One unexpected complication for Pia Brandt was a succession of moves before taking the plunge to buy her own establishment with husband Joakim. “During the first 10 years, I was renting and moving stables seven times! At Chantilly, unlike at Maisons-Laffitte, all the stables are privately owned, so with changing requirements as my number of horses varied and owners selling the stables I was occupying, it was an unsettled time. We’re settled now since buying our yard, and although I have no regrets about coming to Chantilly, I am not sure that I would make the same decision if I had a second chance. It’s the most competitive and most expensive place in France to train. In a parallel world, if I had my chance again, maybe I would choose the French provinces or Deauville!”
A recent addition to the Chantilly trainers’ ranks, Tim Donworth saddled his first runners last September and ended the year with impressive statistics of five winners plus five placed horses for fifteen outings.


The Godolphin Flying Start graduate and former assistant to Nicolas Clement and Jean-Claude Rouget is adamant that Chantilly is the best choice. “I have an international clientele, and this is where they want to be in France”, Tim says. However just a few years ago, the ambitious young Irishman had not even considered France, nevermind Chantilly. “It was all a bit of a mistake, or an accident in any case… I had spent time with Tom Morley in America during the Flying Start and loved it over there, so my aim was to go back. Christophe Clement offered me a role but he didn’t need me until six months later. He arranged for me to work for his brother Nicolas in the meantime, and that’s how I ended up in Chantilly.” Tim goes on to say, “The timing worked out well as while I was there, his assistant Laura Vänskä left [the Finnish national and Flying Start graduate is set to add another nationality to the Chantilly roster when she sets up in the town this spring], so Nicolas asked me to stay on. Wonderment had won a Gp. 1 in the same week, so he managed to twist my arm!

“After a couple of years I decided to take the trainers course, although in all honesty I didn’t expect to pass. I tell people that it’s a fluke that I did pass, but to be honest I worked flat out for two months to prepare. The exams are definitely harder here in France than in Britain and Ireland; although I haven’t been through the process there, I have plenty of friends who have done. The language barrier is huge, but even for a fluent French speaker, the exam is hard. There are various subjects including the rules of racing, a big part on equine health, and then business planning which requires reams of Excel documents. The business plan is presented to a panel of assessors selected by France Galop stewards, including retired and active racing professionals, stewards etc.; and they give you a good grilling!”
Tim Donworth admits his French was “really shockingly bad” on arrival with Nicolas Clement, and although he progressed enough to pass the France Galop exams, he hit a real learning curve when deciding to further his racing education with Jean-Claude Rouget. “I thought that if I was going to train here, I should get more experience and see more of the country. I was in at the deep end as Rouget didn’t speak a word of English to me”, Tim says. “But I loved it at his yard in Pau—at the Cagnes sur Mer meeting and at Deauville—and got on really well with the boss as well as his assistants Jean-René Dubosc and Jean-Bernard Roth who I regularly ring for advice.
I also met my partner Lavinia Brogi in Pau. She’s Italian, the sister of trainer Simone Brogi, and is a great help riding most of my gallops.”

Despite enjoying this period in three of the four corners of France, Chantilly was where Donworth wanted to be, and he now rents part of Nicolas Clement’s yard plus boxes for his juvenile fillies in Pia and Joakim Brandt’s stable. “I’m really fortunate to have my horses stabled in two Gp. 1 yards. Nicolas is like family to me and is a great help. For instance, his head lad François works for me for an hour a day and is fantastic for keeping things in order. I did the trainers course with Joakim Brandt and was delighted when he and Pia offered me the space in their yard, which is just across the street and very convenient.”
Tim Donworth is well on his way to becoming an adopted Frenchman, and his only reserve concerning his situation is opportunities for certain categories of horse. “The programme kills me for older horses, which have arrived from abroad. Those which aren’t up to stakes level are really difficult to place as you have to almost have a Listed horse to be competitive in Class 1 and 2 races. It’s tricky, but knowing the programme book is key to having winners.”
Results so far bode well, and Donworth has high hopes for the future. “I’m really pleased with my two-year-olds and I intend to run them early. They’ve been rocking and rolling for a while now, and I bought precocious ones as I haven’t many older horses and need to get the results to get noticed.”
One Chantilly trainer who has been noticed on the international stage already in 2022 is Hiroo Shimizu, whose Pevensey Bay came with a sweeping run to lift the Gp. 2 Cape Verdi Stakes at Meydan in January. The mare was one of a handful that the unconventional Japanese trainer inherited from the recently retired John Hammond, whose stable he now occupies. “I was present for the win in Dubai, but I don’t get excited or emotional. I soon move on to think about the next challenge.”
Shimizu doesn’t fit the mould of your regular trainer. Dressed in scruffy, baggy trousers and sporting a thick woolly hat with earflaps, which looks more appropriate for Arctic exploration than nurturing blue-blooded thoroughbreds, he quietly indicates some of his Classic hopes turned out in the stable paddocks.
When he arrived in France in 2008 to work as a stable lad for Pascal Bary and then Fabrice Chappet, making race entries— nevermind Classic entries—was far from his mind. “I knew [fellow Chantilly trainer] Satoshi Kobayashi and [Japanese specialist bloodstock agent] Patrick Barbe, which is why I chose to come to France; but I hadn’t considered training.”

It was discussions with francophile Japanese training legend Katsuhiko Sumii—a regular in Chantilly whether with Arc runners or for a busman’s holiday which encouraged him to take the plunge, and contrary to many of his colleagues—he found the France Galop exams a mere formality. “They were very easy!” Shimizu admits.

I’M REALLY FORTUNATE TO HAVE MY HORSES STABLED IN TWO GP. 1 YARDS. NICOLAS IS LIKE FAMILY TO ME AND IS A GREAT HELP. I DID THE TRAINERS COURSE WITH JOAKIM BRANDT AND WAS DELIGHTED WHEN HE AND PIA OFFERED ME THE SPACE IN THEIR YARD.”
CHANTILLY-BASED TRAINER TIM DONWORTH


“I went to one of the best schools in Japan and so I am used to learning. I finished the exams with plenty of time to spare! When I first came to this country, I didn’t speak any French but now I can manage well with a Japanese accent. I think it’s a question of respect for the local population that expatriates should learn the language.”
In addition to the language, Shimizu has plunged into the programme book and specificities of the French racetracks. “In Japan all racecourses have similar ground conditions, whereas here, there is more diversity in the surface and track profiles. As for the programme, in Japan there are 2000m races for two-year-olds in June; but here you have to wait with longer distance types. In Japan people tend to be very disciplined and can sometimes lack initiative. I like the outlook here where you can do whatever you want!”

Whatever you want… within reason and within a strict framework as far as the obtention of the official licence is concerned. France Galop delegates the organisation of the trainers’ course and exams to their educational arm, the AFASEC, and training coordinator
Pierre-Henri Bas explains, “There are two sessions each year for applicants to obtain a professional licence. The training takes place during a five-week residential course, which includes 175 hours of lessons and terminates with three written exams and an oral and written presentation of the candidates’ business plan. The business module is a major part of the course and covers subjects such as management, accountancy and social legislation. We also study the rules and regulations of racing, matters concerning horses’ health, feeding and sporting performance and finally communication.”
With some general knowledge and English language thrown in for good measure, the procedure represents a real “back to school” experience for aspiring trainers who are expected to study hard. “Over recent years the success rate has been around 80%”, continues Bas. “Our aim is to evaluate the competences of individuals for the challenges involved in being a professional trainer. We have no interest in handing out licences for the trainer to fail just weeks or months later. Indeed we have a follow-up scheme whereby two of our representatives provide advice and guidance to newly qualified trainers, and they must complete an assessment after two years of activity.”
As for trainers who hold a licence in another country and wish to transfer to France, Darius Zawiejski who is responsible for France Galop’s licensing department confirms, “These requests are examined on a case-by-case basis. We look at the professional’s CV and experience in his or her home country and some may be exempt from passing certain modules or parts of the exams. Derogations do occur, but they are quite rare; and foreign applicants, from whichever country, are treated in exactly the same way as French applicants.” So any trainers hoping to take advantage of France’s enviable prize money and excellent facilities should be warned: They will need to be willing to put their heads down and study, en français!
IN JAPAN PEOPLE TEND TO BE VERY DISCIPLINED AND CAN SOMETIMES LACK INITIATIVE. I LIKE THE OUTLOOK HERE WHERE YOU CAN DO WHATEVER YOU WANT!”
HIROO SHIMIZU




We didn’t know how good the southern hemisphere sprinters were until they arrived at Ascot; and we didn’t know how good the European middle-distance and staying horses were until they travelled to Australia or were exported to Hong Kong. Now we’re seeing Japanese horses as a force to be reckoned with, and they’re not travelling for prize money. The big stage establishes the big player.
But still, global competition was only for the big players and stardom was the attraction, not money. The Gp. 1 champions competing abroad had earned their airfare already. Those below simply couldn’t afford to travel to take them on.
With the two recent problems—the global pandemic and the more localised Brexit—travel should have become harder and, indeed, we’ve seen from past pages here that travel between
France, Ireland and Britain—the busiest thoroughbred routes— has decreased quite significantly as a result.

For many trainers, however, those problems have not been a deterrent. The lucrative prizes abroad are worth the added effort and paperwork to plunder. Whether there are smaller yards trying to target better prize money to pay their way or owners seeking black type for their horses, a more flexible approach to the programme can pay dividends—especially for those who think out of the box and look further afield or to lesser-known countries.
Sir Mark Prescott is a prime example of using the European race programme to enhance the stud value of his horses. He is already synonymous with working backwards from a big handicap target to ensure the most efficient and beneficial preparation possible. Now he is transferring those tactics to target what might be perceived as Europe’s less competitive Gp. 1 races.

The race of the season in 2021 turned out to be at Hoppegarten at the beginning of August when Alpinista won the Gp. 1 Grosser Preis von Berlin for Sir Mark Prescott and owner-breeder Miss Kirsten Rausing, winning €106,900 as well as enhanced black type.


More interestingly, finishing second that afternoon was Torquator Tasso, trained by Marcel Weiss. And we all know what he did next, taking the Gp. 1 Grosser Preis von Baden en route to the Prix de l’Arc de Triomphe. In third place was Charlie Appleby’s Walton Street, who won the Gr. 1 Canadian International on his next start. Alpinista meanwhile continued on her unbeaten season to claim the Gp. 1 Preis von Europa at Cologne in September and the Gp. 1 Grosser Preis von Bayern at Munich in November, taking her earnings to €509,314 in the process.
That was a nice case of black type and prize money, but even for the lower grade horse that doesn’t aspire to Pattern level, there are lucrative opportunities beyond Britain where many trainers are struggling to cope with what amounts to the ‘poor relation’ in prize money terms.
Amy Murphy is just one of several British trainers to open a satellite yard in France, where she describes the prize money as
‘out of this world’. Gay Kelleway and Paul George are among those to also cite prize money as the motivation, as well as the additional temporary fix of avoiding Brexit issues with French runners.
Over-wintering horses in Dubai is popular with those that can afford to do so, but France also offers a more cost-effective chance to get winter sun on their backs while competing for prize money that is higher than the average British winter all-weather handicap. Marie-Laure Treal, assistant director at Cagnes sur Mer, tells us, “Until 13 March, the Winter Meeting of the Hippodrome de la Côte d’Azur offers 59 race meetings. Trainers may rent boxes for the period at €50 per box per month and accommodation is offered for stable staff, allocated according to the different requests and availability.”
While France is the obvious choice when looking for increased earning potential, other nations are also trying to attract international attention with eye-catching purses. As Irish trainer Adrian McGuinness points out in relation to Meydan’s Gp. 1
THERE’S €700,000 ON OFFER TO THE WINNER. I COULD WIN MORE IN ONE RACE THAN I WON IN THE WHOLE SEASON IN IRELAND LAST YEAR, DESPITE THE FACT I HAD THE BEST CAMPAIGN OF MY LIFE.”
ADRIAN MCGUINNESS ON THE ALQUOZ
SPRINT’S PRIZE FUNDThe Belgian Galop Federation has many racing opportunities with prize money from €5,000 to €8,000. ABOVE: Norway’s Ovrevoll hosts the Norsk Derby in August with a value of €121,970 and the Oslo Cup in June, a value of €53,000.
Al Quoz Sprint, “There’s €700,000 on offer to the winner. I could win more in one race than I won in the whole season in Ireland last year, despite the fact I had the best campaign of my life.” He also points out that the runner-up prize of €300,000 is higher than the winner’s purse in the Gp. 1 Prix de l’Abbaye.
With emerging countries such as Qatar, Saudi Arabia and even Libya using money to secure their instant place in the international calendar, trainers need to be more broadminded than ever when planning campaigns.
Many opportunities for an average rated horse are much closer to home and easier to target. The prize money might not be eye-watering, but neither is the competitiveness in comparison to similar races at home.
Marcel De Bruyne, MvG, Belgian Galop Federation, tells us, “Our showpiece—the Prince Rose, a National Listed Race over 2100m—will be run in Ostend in August with total prize money of €12,800, with €8,000 for the winner.
“This race is open for three-year-olds and older who have never been placed in the first five of a Pattern race. The weights are 52.5kg for three-year-olds and 56kg for four-yearolds and older. Horses that have won or been placed second or third in minor races will have to carry extra weight.
“Some other races can be interesting for foreign runners in Ostend. The four races I highlight each have a total prize money of €8,000, with €5,000 for the winner. Three conditions races in July and August are the Miler Cup, 1600m; the Prijs Half Oogst & BFG Galop, 1800m; and the Prijs BFG & Nymphenburger, 2200m.
“They are for four-year-old horses and older without a handicap value or a value equal or lower than 30kg (66 lbs) and they carry 55kg (121 Ibs). Penalties for prize money received for wins and places since 1 July 2021 are 1kg per €1,000.
“Then we have one handicap, the UAE Sprint Cup over 1000m in August for four-year-olds and older with a handicap value equal or lower than 30kg.”
See the the complete list of races and conditions here: www.bgalopf.be/Meetings.htm
Scandinavia offers a great deal of potential and Svensk Galopp highlights for foreign visitors the 2400m Gr. 3 Stockholm Cup—Sweden’s major race—run at Bro Park in September and worth €155,000. The Svensk Derby is worth €120,289, the Listed Zawawi Cup €48,282; and supporting races include the Listed Lanwades Stud Stakes, Listed Bro Park Sprint Championship and the 1400m Appel Au Maitre Svealandlöpning—the latter being Sweden’s most important two-year-old race, often attracting foreign runners. Svensk Galopp is a rising star in the racing world with plans for another new course project in Skåne.
In Norway, the Norsk Derby at Ovrevoll in August has a value of €121,970 and the Gp.3 Oslo Cup in June, a value of €53,000.
Spain is another country on our doorstep but perhaps off the radar. The Madrid Grand Prix over 2500m at the end of June is the major summer highlight, worth €60,000. They race most of the year, with a break from 29 December to 6 March.
The autumn-winter season begins 11 September, the highlight being Champions Day 16 October. The Champions Day card includes the Gran Premio Memorial Duque de Toledo, over 2400m with a value of €68,000; and the Gran Premio Ruban, over 1200m worth €40,800; as well as a strong supporting card and lucrative added premiums of €5,000 for Spanish-breds.

This year Oostende Koerse organizes nine Monday meetings from the 4th of July till the 29th of August.
Five of these meetings are Premium Race Days, supported by France Galop and the French PMU. On Premium Race Days, four to six races are planned and the guaranteed prize money for the winner varies from 5000€ for the highlight of the day to 2000€ for allowance races.
Race conditions are published on www.bgalopf.be. They are in French and Flemish but can be provided in English - as can any other information that is required. Horses trained outside Belgium do not have to qualify for handicaps when they already have a handicap rating in their home country.

These values will be converted to a Belgian Rating. The showpiece of the meeting, the Prince Rose, is a National Listed Race, and the winner will get 8000€. We look forward to welcoming you this summer!
A reminder: Ostend is only 100 km from Calais and less than two hours from Folkestone. The racing surface is turf, the course is right handed and a watering system will guarantee perfect ground.
Scandinavia offers a great deal of potential for foreign visitors including the Gr. 3 Stockholm Cup—Sweden’s major race—run at Bro Park in September and worth €155,000.


The premiums are always a boost, and every European country contributing to the European Breeders Fund also hosts a wide range of races aimed to improve opportunities at a grassroots level.
Rachael Gowland of the British EBF tells us, “If a horse finishes sixth or better in any of the EBF races in Britain, it will be eligible to enter for one of the two finals. Each final is run over 7f and has a value of £100,000, with prize money down to eighth place.
“The colts’ and geldings’ final will be at York Friday 7 October and the fillies’ final at Goodwood Tuesday 6 September. The EBF is contributing £50,000 for each race, and we were very lucky that York and Goodwood both came back to us and offered to match our prize fund.
“The EBF is a cooperative, and all member jurisdictions benefit from a pool of international stallion registrations; an EBF-registered horse is qualified to run in EBF races in any member country.”
Simon Sweeting, chairman of the British EBF, explains, “With a reduction in racing in 2020, came a small surplus of funds for the British EBF. The trustees were keen to make sure that this money was re-focused to do the maximum good it could for the industry. This series not only provides tantalising prize money targets but also aims to add the EBF’s weight to encouraging owners to re-invest at the yearling sales. With no early closing stages and over 100 chances to qualify a horse, we hope that owners and trainers will support this new initiative.”
In Ireland, the Median Sires Series consists of 26 races each worth a minimum €25,000. The Irish EBF Ballyhane Stakes is the showcase.
The Irish EBF Auction Series for two-year-olds bought at auction for €72,000 or less is worth a minimum of €20,000 per race and has two finals, the main one worth €120,000. The Connolly’s Red Mills Irish EBF Auction Hurdle Series and Irish EBF Auction Bumper cater for the National Hunt horses in a similar fashion.
IF A HORSE FINISHES SIXTH OR BETTER IN ANY OF THE EBF RACES IN BRITAIN, IT WILL BE ELIGIBLE TO ENTER FOR ONE OF THE TWO FINALS. EACH FINAL IS RUN OVER 7F AND HAS A VALUE OF £100,000, WITH PRIZE MONEY DOWN TO EIGHTH PLACE.”
RACHAEL GOWLAND – BRITISH EBFEvery European country contributing to the EBF also hosts a wide range of races aimed to improve opportunities at a grassroots level.
Friday 20th May


Saturday 21st May
Saturday 28th May


Equine infectious disease occurrences remain an ever-present threat, irrespective of the country where a horse resides. With climate change and increased international horse movements, monitoring and surveillance of infectious disease is more important than ever. But how is this conducted in our equine population?
In Northern Europe and the majority of countries worldwide, there are three infectious respiratory diseases commonly found to be circulating in horse populations (referred to as ‘endemic’). These include the viral diseases: equine influenza and equine herpes; and the bacterial disease: strangles. It is essential that horse keepers and their veterinary surgeons remain vigilant and knowledgeable around how these diseases present to ensure rapid implementation of control measures if they occur and more importantly what actions to take to prevent them in the first place.
Identifying and controlling infectious diseases when they occur is important to limit both the number of infected horses on a premises and the disruptive and costly effects that disease can have on commercial enterprises, as well as avoiding the spread of infection to the wider horse population. To optimise control and prevention measures, diseases are monitored at a national and international level, through surveillance activities.
There are two main ways that equine surveillance is conducted:
Diseases that are notifiable under veterinary or human health legislation in horses may include (but are not limited to and will have country-specific designation): African Horse Sickness (AHS), Contagious Equine Metritis (CEM), Dourine, Equine Viral Arteritis (EVA), Equine Infectious Anaemia (EIA), Glanders and West Nile fever. These diseases have been designated as notifiable, either due to their potential implications for human health, equine health or trade. Statutory reporting is required if a disease is suspected due to suspicious clinical signs or confirmed through diagnostic testing, such as those recommended by the HBLB International Codes of Practice before horses are bred each year. The specific approaches to their occurrences will be disease- and countrydependent but may include movement restrictions and testing of the in-contact population as a minimum. Information gathered from these outbreak investigations is evaluated and shared with the wider industry, through platforms such as the World Organisation for Animal Health - World Animal Health Information System (OIE-WAHIS) (https://wahis.oie.int).


If a horse is examined and undergoes confirmatory diagnostic testing through a laboratory and either the veterinary surgeon or laboratory contributes to surveillance initiatives, the diagnosis may be reported (Fig. 1, overpage).
Alongside this, epidemiological data relating to horse-specific factors such as the horse’s age, breed, vaccination status and specific factors such as approximate geographical location, number of resident horses on the premises and history of recent horse movements may also be available.
In addition to this, to increase our understanding about pathogens and how they are changing over time, further analysis of the pathogen isolated from the infected horse(s) may be conducted to determine factors such as the particular strain of the pathogen. Information such as this can then be utilised to inform factors such as vaccination requirements.
However, given the necessary voluntary steps that are required for a confirmed disease diagnosis to reach the reporting stage through this surveillance method, reported cases may not reflect the true extent of disease in a particular region or country.
Also, some bias in the type of outbreaks that get reported may exist as detection and reporting may favour more severe cases, particular groups that undergo required testing or be more likely to be sampled due to subsidised testing costs existing in a particular country.
Country-specific initiatives may be available to encourage diagnostic testing of suspect infectious cases through incentives such as subsidised laboratory fees. In the UK, equine vets can submit nasopharyngeal swab samples from horses with signs that could be indicative of equine influenza, for free PCR testing at a designated laboratory—with this scheme funded by the Horserace Betting Levy Board (HBLB) and overseen by Equine Infectious Disease Surveillance (EIDS), University of Cambridge, United Kingdom.
In addition to this scheme, EIDS maintains a surveillance network of all commercial laboratories conducting equine influenza testing in the UK, encouraging the voluntary reporting of positive samples and the sharing of associated epidemiological and virological information. Both schemes enable monitoring of equine influenza in the UK, and this is essential given that equine influenza
viruses naturally change and adapt, giving the potential for new strains to be more infectious or to emerge beyond the protection imparted by current vaccines. In addition to equine influenza, the UK closely monitors laboratory-confirmed occurrences of equine herpes virus-1 (EHV-1), given its ability to cause neurological signs and abortion in pregnant mares and death of newborn foals.
Strangles is also under surveillance with epidemiological and bacteriological data collected and analysed to improve our understanding of this frustrating contagious disease and contribute to improving its control and prevention.


Country-specific reporting platforms exist worldwide, and these predominantly notify stakeholders—usually through email alerts— about laboratory-confirmed disease occurrences in the reporting country. Examples in Europe include:


FRANCE : Réseau D’épidémio-Surveillance En Pathologie Équine (RESPE, www.respe.net)



THE NETHERLANDS: Surveillance Equine Infectious Disease Netherlands (SEIN, www.seinalerts.nl)


BELGIUM: Equi Focus Point Belgium (EFPB, www.efpb.be)
SWITZERLAND: Equinella (www.equinella.ch)
Complementary to this, the International Collating Centre (ICC) is overseen by EIDS and supported by the International Thoroughbred Breeders’ Federation (ITBF) and International Equestrian Federation (FEI) and has for over 30 years collated outbreak reports from available country-specific reporting
contacts and platforms worldwide. In addition, EIDS receives reports directly from veterinary surgeons and diagnostic laboratories. Collated reports are sent to registered subscribers on an almost daily basis through an email that contains embedded links to specific ICC outbreak alerts.
A quarterly summary report is also produced and emailed to subscribers four times a year and is available in the resources and archive section of the ICC website (https://equinesurveillance. org/iccview/).
Reported outbreaks are predominately made up of at least one case that has had the diagnosis confirmed through laboratory testing. It is therefore expected that those outbreaks that reach the reporting stage by the ICC will not reflect true infectious disease frequency within the international equine population; and a country with no reported outbreaks of a disease does not necessarily mean that the disease is not present in that country.
There is an interactive ICC website enabling analysis of all international infectious disease outbreaks reported through the ICC, which was launched in August 2019; and outbreak data for all of 2019 onwards is available through this platform. Through the ICC, infectious disease outbreak information is shared with stakeholders throughout the world, ensuring people remain up to date through this active communication network.
In addition to the ICC, EIDS has an equine influenza-specific platform, EquiFluNet (www.equinesurveillance.org/equiflunet), which presents influenza outbreak reports for the UK and worldwide.
7.Anonymised
information shared through disease reporting platforms, increasing awareness of the signs and future reporting
2. Equine keeper indentifies that their horse is sick and contacts their vet
4. Diagnostic samples are taken and submitted to a laboratory
5.Laboratory
obtains a diagnosis6. Diagnosis reported to a surveillance initiative
3. Case is seen by a vet

European countries reporting equine influenza outbreaks through the ICC for 2019, 2020 and 2021



• Equine influenza – During 2019, Europe experienced an epidemic of equine influenza with widespread welfare and economic effects, including the temporary ceasing of horseracing in the UK. During 2021, influenza occurrences in Europe reported by the ICC returned to a more expected level (Fig. 2). However, the potential of viral strain changes alongside international horse movements makes monitoring and surveillance of this virus essential.
• Equine herpesvirus-1 (EHV-1) – EHV-1 is endemic in Europe, and the ICC regularly reports on occurrences of EHV-1 disease. An example of an ICC report released during 2020 detailed an outbreak of EHV-1 neurological disease on a premises in Hampshire, United Kingdom, with multiple equine fatalities (Fig. 3). Another example of an ICC report included a widespread neurological EHV-1 outbreak that occurred in Spain at several international show jumping events during 2021 (Fig. 4).
• West Nile fever (WNF) – WNF is caused by West Nile virus (WNV) by biting mosquitoes, with birds acting as sources of the virus. It is a zoonotic disease, meaning humans can become infected if bitten by an infected mosquito. The ICC has reported equine cases across Europe over recent years (Fig. 5). Given that many countries in Europe remain ‘free’ from WNV, it is still possible for horses to have neurological signs such as weakness and incoordination or even death following infection. Humans can also be affected if bitten by an infected mosquito, so monitoring and surveillance of equine WNF occurrences, alongside mosquito, bird and human surveillance are essential. By way of example, WNV was confirmed in birds and humans in the Netherlands for the first time in 2020, but as of March 2022, it has not yet been confirmed in horses.
Having an appreciation of how and why surveillance of equine infectious diseases are conducted helps to improve engagement with and encourage an increased contribution to surveillance initiatives. A well-informed view on equine infectious disease outbreaks worldwide ensures continued advancements in enhancing control and prevention measures. This in turn will help reduce the risk from disease outbreaks and ensure the industry can continue to operate to its full potential.
Report Date: 2020-01-07 AHT UK - Hampshire
EHV-1 - Neurological
Location of event Description
For full ICC event analysis please visit our website FIG
On 7 January 2020, AHT confirmed a case of EHV-1 neurological disease on a premises in Hampshire. The a ected horse was an unvaccinated Thoroughbred-cross mare that presented with pyrexia, lethargy inappetence, lymphadenopathy limb oedema and ataxia and was subsequently euthanased after becoming ecumbent. The positive diagnosis was confirmed by PCR on a nasopharyngeal swab. Nasopharyngeal swabs taken from three mildly clinically a ected (but non-neurological) contacts also tested positive for EHV-1 by PCR. The a ected premises has voluntarily closed and disease control measures have been implemented under veterinary supervision.
Report Date:
Reported by:
Location of event













ABOVE – FIG 3 & 4
On 20 February 2021, the FEI Veterinary Department was informed that four horses that had participated at the CES Valencia Spring Tour 2021 jumping event in Spain tested positive to EHV-1 following PCR laboratory analysis of a nasopharyngeal swab. The a ected horses had left the venue on 14 February and showed clinical signs consistent with the disease shortly afterwards. As of 21 February 2021, 50 horses at the event venue developed pyrexia and one horse showed neurological signs. All athletes whose horses have attended and left the event since 1 February 2021 are being traced. They are required to implement biosecurity measures and testing of their horses as well as any in-contact horses. The competition at Valencia has been cancelled. As of 22 February 2021, 150 horses remain on the venue and are subject to biosecurity measures and testing under the direction of the FEI veterinarians and local veterinary authority Any horse that has attended the event since 1 February 2021 has been prevented from attending any future FEI events until the FEI s EHV-1 testing requirements have been fulfilled.
The International Collating Centre (www.equinesurveillance.org/iccview) reports detailing outbreaks of equine herpesvirus-1 neurological disease in Hampshire, United Kingdom in January 2020 and in Valencia, Spain in February 2021.





Sources for further information about equine infectious diseases and their control and prevention are available at:
• Horserace Betting Levy Board’s International Codes of Practice 2021: https://codes.hblb.org.uk
• Equine Infectious Disease Surveillance (EIDS) website, hosting the International Collating Centre (ICC) and Equiflunet: www.equinesurveillance.org
• Sign up to receive International Collating Centre reports by contacting EIDS: equinesurveillance@gmail.com
Darker colour shows more outbreaks

The year 2022 heralds a major step forward in racehorse welfare and a world first for British racecourses. With a generous grant from the Racing Foundation and additional support from the RCA, ARVS and NTF, all British racecourses are to be provided with fracture support systems (Fig. 1). These consist of two compression boots and two flexion splints—both for use in the forelimbs—and a set of aluminium modular adjustable splints. One size of each compression boot and flexion splint fits the majority of flat racehorses and the other larger jump racehorses. Together, these provide appropriate rigid external support for the vast majority of limb fractures that occur during racing. The general principles are that management of all fractures is optimised by applying rapid and appropriate support to provide stability, reduce pain and relieve anxiety.



In the last 25 years, there have been major improvements in fracture treatment due to significant advances in surgical techniques (particularly with internal fixation), minimally invasive approaches (arthroscopy) and the use of computed tomography (CT). Arthroscopy and CT allow accurate mapping and alignment of fractures, which is important for all horses and critical for athletic soundness. All have contributed to improving survival rates; and it is now safe to say that with correct care, the vast majority of horses that sustain fractures in racing can be saved. Equally importantly, many can also return to full athletic function including racing.
Fracture incidences and locations vary geographically and are influenced by race types, track surfaces and conditions. There is good evidence that the majority of non-fall–related fractures (i.e., those occurring in flat racing and between obstacles in jump racing) are caused by bone fatigue. This is precipitated by the absolute loads applied to a bone, their speed/ frequency and the direction of force application. As seen with stress or fatigue, failure in other high-performance working materials such as aeroplanes or formula one cars—in which applied forces are relatively consistent—fractures in racehorse bones occur at common sites, in particular configurations and follow similar courses. Once the fracture location has been identified, means of counteracting forces that distract (separate) the bone parts can therefore be reliably predicted and countered.
Worldwide, the single most common racing fracture is that of the metacarpal/metatarsal condyles (condylar fracture). In Europe, the second most common fracture is a sagittal/ parasagittal fracture of the proximal phalanx (split pastern). Both are most frequent in the forelimbs. In the United States, particularly when racing on dirt, fractures of the proximal sesamoid bones (almost always in the forelimbs) are the most common reason for on-course euthanasia. They occur less frequently when racing on turf but are seen at increased frequency on all-weather surfaces in the UK.
There is no specific data documenting outcomes of horses with sustained fractures on racecourses. However, there is solid data for the two commonest racing injuries. The figures below are a meta-analysis of published data worldwide.
• Repaired incomplete fractures; 80% returned to racing
• Complete non-displaced fractures; 66% of repaired fractures returned to racing
• Displaced fractures; 51% raced following repair
• Propagating fractures; 40% raced following repair

• Short incomplete fractures; 65% returned to racing
• Long incomplete fractures; 61% returned to racing
• Complete fractures; 51% returned to racing
• Comminuted fractures in most circumstances end racing careers but with appropriate support and surgical repair, many horses can be saved. There is only one comprehensive series of 64 cases in the literature of which 45 (70%) of treated cases survived.

The science behind the development of fracture support systems comes from two directions. The first is data collected from racecourse injuries and the second, improved understanding of fracture courses and behaviour. Data collected from UK flat racecourses between 2000 and 2013 demonstrated that 66% of fractures occurred in the lower limb (from knee and hock down); and of that, over 50% of fractures involved the fetlock joints. Condylar fractures are most common, representing 27% of all reported fractures; and of these, approximately two-thirds occurred in the forelimbs. Split pasterns were the second most common, accounting for 19% of all fractures with three quarters of these occurring in the forelimbs. These fractures have predictable planes and courses which means that once recognised, they can effectively be immobilised in a standard manner that is optimal for each fracture type. For condylar fractures and split pasterns, this principally involves extension of the fetlock joint. By contrast, in order to preserve soft tissues and blood supply to the lower limb,

fractures of the sesamoid bones (which represent 7% of recorded fractures in UK flat racing) require fetlock flexion.
The compression boot (Fig. 2) is readily applied ‘trackside’ and can be used to stabilise most distal forelimb fractures sufficiently for horses to be moved off of the course. It is the temporary immobilisation of choice for forelimb condylar fractures and split pasterns (Fig. 3). Radiographs can be taken with the boot in place (Fig. 4), and this can be maintained for transport. The boot is a rigid construct of fibreglass made from a single mould. The divided front portion is contiguous with a foot plate on which the back of the boot is hinged. Removable foot inserts are provided to make minor adjustments for hoof size. The boot is lined with foam rubber and has a rubber sole plate, which protects the shell and provides a cushion grip for the foot. When the boot is opened, the injured limb is placed into the front of the boot while the back is closed and secured by sequential adjustment of ski boot clips. When the boot edges are opposed (it cannot be over-tightened), immobilisation is secure. It is made with a fixed fetlock angle of 150° which counteracts distracting forces and allows horses to weight-bear and load the limb to walk.

THE COMPRESSION BOOT IS READILY APPLIED ‘TRACKSIDE’ AND CAN BE USED TO STABILISE MOST DISTAL FORELIMB FRACTURES SUFFICIENTLY FOR HORSES TO BE MOVED OFF OF THE COURSE.”

Portable

Easy to perform: scan plus analysis takes only minutes

Standardized & highly reproducible
3-D visualization & tissue characterization

Early detection overstrain & degeneration
Precise diagnosis & prognostication
Targeted & minimally invasive treatment
Objective evaluation & monitoring of therapy
Guided rehabilitation
www.UTCimaging.com
Flexion splints (Fig. 5) are critical for the survival of horses with breakdown injuries such as sesamoid fractures. They are also suitable for other lower limb injuries, which are supported by fetlock and pastern flexion. The splints are made of aluminium with a secure footplate and conjoined foam-lined front splint, which is angled at 30° at the level of the coffin joint and extends to the top of the cannon. There is a shallow foam-covered concavity in which the upper cannon sits, allowing the horse to lean into the splint and load the leg while flexed. The splint is secured to the leg with nylon and Velcro straps.








The aluminium splints (Fig. 6) are lightweight, adjustable and modular to fit individual horse and regional needs. They are spring-locked and light but rigid, secure and are tolerated well. In the hindlimb, the reciprocal apparatus that combines stifle, hock and fetlock joint positions precludes use of a compression boot. However, modular splints provide rigid support for condylar fractures and split pasterns in hindlimbs and are secured over a bandage to create a parallel sided tube, on the inside and outside of the limb. The splints can also be adjusted and assembled to splint fractures that occur less commonly above the fetlock (Fig. 7).

FLEXION SPLINTS ARE CRITICAL FOR THE SURVIVAL OF HORSES WITH BREAKDOWN INJURIES SUCH AS SESAMOID FRACTURES. THEY ARE ALSO SUITABLE FOR OTHER LOWER LIMB INJURIES.”
Appropriate immobilisation effectively stops fracture progression (i.e,. getting worse), which not only improves the horse’s prospects for recovery but also provides effective relief from pain and anxiety. As flight animals, loss of limb control or function is a major contributor to stress. The relief provided by effective immobilisation is substantially greater than provided by any pain killer or sedative. It is also recognised that when fractures occur in the high adrenalin environment of racing, horses exhibit latent pain syndrome. Application of appropriate rigid support at this time (i.e., on the course) limits pain generation and allows humane movement for considered evaluation, X-ray, etc. away from the racetrack.
Techniques for application of the boots and splints are taught to racecourse veterinary surgeons at annual seminars facilitated by the Association of Racecourse Veterinary Surgeons (ARVS). The RCA has provided
forms to record use and to collect data centrally which, in the fullness of time, will determine impact and help guide future welfare strategies. The equipment is currently being rolled out and will be available at all British racecourses at the start of the 2022 flat race season.
“The introduction of these boots and splints to all racecourses in Great Britain represents a major advancement for the welfare of racehorses. This demonstrates the collective desire of all the sports participants to show to a wider society the ambition to continually improve racehorse welfare.”
James Given, BHA Director of Equine Health and Welfare
“The fracture support kit is a major advance in the treatment of horses on the racetrack. It allows immediate effective support to be applied to an injured horse, resulting in pain control and stability, facilitating safe transport from the racecourse to a centre of excellence without risk of exacerbating the injury. This will optimise the chance of horses to return to athletic function. This innovation must be seen as a major step forward in horse welfare for the participants in racing and all other equine disciplines.”



Simon Knapp, Horse Welfare Board
“This new equipment will provide the best possible chance for an injury to be properly assessed while discomfort to the horse is significantly reduced [to] give the best chance of future rehabilitation.”
Caroline Davies, RCA Racecourse Services Director“The importance of the fracture support kits cannot be overstated. In providing stability and support, it gives horses the best possible chance of recovery.”
 Emma Lavelle, NTF President
Emma Lavelle, NTF President
“As a clerk of the course, my number-one priority is the safety of the horses and riders who participate in racing, and we constantly seek ways to improve in that area. The equine fracture support kits are an excellent addition to the equipment available to racecourse veterinary teams and a vital step forward in horse welfare. It is so important for both the immediate comfort and long-term prognosis of a horse who suffers a fracture that the injury is immobilised, and the fracture support kits provide that stability quickly and effectively.”
Andrew Cooper, Clerk of the Course, Sandown Park and Epsom Downs
“I have no doubt that in time no racecourse in the world which purports to take equine welfare seriously will be without a set of fracture support kits.”
Armytage, Daily TelegraphMarcus
HAS BEEN WIDELY WELCOMED BY THE INDUSTRY.FIG 7

This year’s winner and placed horses in the Gran Premio de Madrid—run on Saturday, June 25th at Madrid’s La Zarzuela racetrack—will qualify for ‘Black Type’ in sales catalogues. This follows a decision by the European Pattern Committee (EPC) to approve a new ‘flagship race’ scheme designed to give ‘emerging’ EMHF racing nations a leg up in their quest for international recognition of their best races.
When news of the decision broke, the deadline for entries for this historical race—run on turf for three-year-olds and up, over 2,500 metres with a prize fund of €68,000—was days away. So, the track extended the deadline by a few days, while its new status was publicised. This paid dividends, with two additional entries received from Great Britain and France. There is still ‘room at the inn’, there being a Supplementary Entry stage on June 20th.
La Zarzuela’s director-general, Alvaro Gutierrez, gave his reaction to the development: “For La Zarzuela, who have just celebrated 80 years since opening, and for the whole Spanish horseracing industry—to get back a Black Type race means a lot. We have been working over recent years to be more international and develop our races in quality and level. We have very good tracks and very good professionals that demonstrate, whenever they compete abroad, the quality of our horses. Our local Category A races are really well-situated in prize money terms. We deserve to be recognised by IFHA again with a Black Type race—it will help us to continue developing and improving our horse racing program.”

The Spanish Jockey Club’s Paulino Ojanguren, an EMHF executive council member, agrees: “Black Type races mean good horses, good trainers and good jockeys; and that is what people want to see at the racetrack. A race like the Gran Premio de Madrid is a very good reason to attend the meeting and also a reward for everybody who has been involved in horse racing during the last difficult years.”
La Zarzuela is certainly a striking racecourse. Its signature ‘rippled’ grandstand roof, designed way back in the 1930s by pioneering structural engineer Eduardo Torroja, seems to float almost weightlessly above you. But how does its grass track ride?
“La Zarzuela is one of the most beautiful racetracks in Europe”, says Gutierrez. “It is a monument in its own right, which is in the running for World Heritage by UNESCO on the strength of its architecture and legacy. Also, the facilities are really good and the turf track always has the best of care. Horses here need to be fast because the pace normally is strong, they normally need to be suited by fast ground and to be tough, as the 3-furlong final straight is demanding, with the last furlong uphill. So, in essence, quality horses appreciate our racetrack.
“In 2020, before COVID started, we organised an international female jockeys championship and the feedback from jockeys and trainers was universally really good about our facilities and organisation. Prize money payments are made within 21 days. That’s why we have been visited in recent years by international horses and trainers, such as: Carlos Laffon-Parias, Mauricio Delcher-Sanchez, Christophe Ferland, Andrew Balding, Ed Dunlop, Jean-Laurent Dubord and Nicolas Caullery.”
So, what exactly is this ‘flagship race’ policy, how did it come about and what does it mean for other smaller European racing nations?
Europe has long led the way when it comes to the quality control of its pattern. It laudably applies the rules by which races are designated Gp. 1, 2, or 3 or
Listed with a strictness that is unparalleled around the world. But there has long been the feeling that, for those countries without Black Type races, this makes entry into the Black Type ‘club’ unduly difficult. In recent years, the EMHF has been inching closer to finding a proposal that ‘squares this circle’ to the EPC’s approval. It was Jason Morris, racing director at Horse Racing Ireland and newly appointed chair of the EPC, who came up with the formula which got the idea over the line and met with unanimous EPC support. He explains:
“The EPC supported a proposal from Ireland to take supportive action for the development of racing in the smaller EMHF racing nations. Growing the importance of racing in more EMHF countries will potentially produce political, promotional and commercial benefits for the industry throughout Europe. Helping to stimulate interest in racing in more European countries, improving the quality and standards of the racing and breeding industries within a broader swathe of the EMHF, growing potential export and ownership markets, and encouraging greater international participation and political recognition are all potential benefits.”
FOR LA ZARZUELA AND FOR THE WHOLE SPANISH HORSERACING INDUSTRY–TO GET BACK A BLACK TYPE RACE MEANS A LOT. WE HAVE BEEN WORKING OVER RECENT YEARS TO BE MORE INTERNATIONAL AND DEVELOP OUR RACES IN QUALITY AND LEVEL.”
ALVARO GUTIERREZ – LA ZARZUELA RACETRACK
“Leading the way in quality control will remain the EPC’s strong ambition. However, pushing for that objective should not prevent us from assisting the development of the smaller EMHF countries. So, in order to move forwards, the EPC agreed to adopt a more liberal approach and agree to a lower Listed rating requirement on the basis that this would only apply to one race per smaller country.”
The full criteria are these:
• An emerging country must adhere to basic EMHF-defined administration/integrity standards and be a member of the EMHF.
• A maximum of one qualifying race is permitted per emerging country which qualifies on the basis of a lower rating parameter/tolerance level.
• This lower parameter/tolerance level is 5 lbs below the normal Listed race levels (i.e., 95 lbs, rather than 100 lbs, with the exception of fillies/mares and two-year-old races, where the thresholds are lower).
• A race from an emerging country must have achieved this required (lower) rating at least twice in the past three years, meaning that races must have been run at least twice.
• The race’s prize fund must be a minimum of €50,000.
• A qualifying race is given three years to establish itself before being subject to review and could be downgraded if falling below the lower ‘exceptional’ parameter/tolerance level thereafter (with the general principle being that it must either achieve the 5-lb lower average race rating over three years or the annual rating in two years out of the three renewals).
• If a country wishes to seek Listed status for more than one race or Group status for any race, all Black Type races from that country must meet the full normal rating parameters; and the country would then become an associate member of the European Pattern Committee.
Trainers can thus get a good handle on the likely winnability of these Black Type races from knowing that the average rating of the first four home over recent renewals will have been between 95 and 100.
“An aspiration for the EPC”, Morris continues, “would be that the award of Listed status to one race would serve as a catalyst to improve their race programme and horse population, hopefully
propelling them to become associate members in time (allowing more than one race to achieve Listed status if reaching the standard rating parameters).”
No fewer than five countries made applications under the new scheme, despite having only a few weeks in which to do so. In the first year, Spain was the only country whose chosen race rated highly enough, but it is our strong hope that, with more time in which to plan, other countries will be successful in the future.
“It is very pleasing that Spain has already been able to achieve the required level for Listed status to be awarded to the Gran Premio de Madrid and that several other countries were keen to put forward races, which will hopefully qualify for future consideration. The EPC will work with the respective rating authorities on trying to standardise their rating file levels with European norms to facilitate future evaluations.”

“An emerging country with aspirations for a race to be awarded Listed status by the EPC, but not yet achieving the rating requirements, will hopefully take encouragement to target the key race(s) within their jurisdiction for the future with enhanced prize money and promotion to boost the quality of the races. For races in an emerging country to be successful, strong communication of the opportunities internationally and incentives to encourage high quality overseas participation will be important.”
This European scheme could form a blueprint for the development of smaller racing nations in other regions of the globe. Your correspondent represents emerging countries on the International Federation of Horseracing Authorities’ Executive Council, and discussions with counterpart ‘ExCo’ member for the Asian Racing Federation, Bruce Sherwin of New Zealand, have revealed an interest in its adoption in Asia as well.

IT IS VERY PLEASING THAT SPAIN HAS ALREADY BEEN ABLE TO ACHIEVE THE REQUIRED LEVEL FOR LISTED STATUS TO BE AWARDED TO THE GRAN PREMIO DE MADRID.”
JASONMORRIS – HORSE RACING IRELAND Jason Morris “Black Type races mean good horses, good trainers and good jockeys and that is what people want to see at the racetrack.” – Paulino Ojanguren
In a golden spell of several months earlier this jumps season, the exploits of a 12-year-old handicap hurdler named Kansas City Chief and his 21-year-old 7-lb claiming amateur rider Victoria Malzard seemed to be on British television screens almost every Saturday afternoon, ensuring that racing in Jersey (where Malzard is based and the horse is sometimes trained by her mother, Alyson) received perhaps unprecedented publicity. Channel Islands racing does not normally figure high in the consciousness of race fans in Britain—still less, doubtless, in the rest of Europe.
So, what is racing like on these small islands, lying close to the French coast, enjoying a complicated relationship with the United Kingdom? (The Channel Islands—not being part of the UK—were never part of the European Union, so ‘Chexit’ was never a thing.)
There are two Channel Islands racetracks: the CoinShares Les Landes on Jersey and L’Ancresse on Guernsey. The former traditionally stages some nine fixtures annually, bookended by Easter Monday and the late-August bank holiday. It is a lefthanded turf track of one mile’s circumference. The usual pattern is to kick off with a hurdle race. The temporary hurdles are then moved off the track, clearing the way for four races on the level. Last year, most races were run for a £2,800 prize fund, with the feature race of the day worth up to £4,750.
L’Ancresse is a temporary track, having to be laboriously set up and taken down each year. Like Les Landes, a turf course, it is by contrast right-handed, with a circumference of nine furlongs. In recent pre-pandemic years, the big race of the day has been the Ravencroft Channel Islands Handicap, which is over around six furlongs and billed as the richest race on either island, with a prize fund of £5,000.
L’Ancresse normally races on but a single day each year—on the early-May bank holiday. But these are not normal times. There has been no racing on Guernsey since 2019, and 2022 will be the third

blank year in a row. What COVID-19 began, the island’s wildlife has conspired to continue. Trevor Gallienne, Guernsey Race Club President, picks up the story: “We’ve had an invasion of rabbits over the past two years and also massive crow damage to the grass.”
No Guernsey-based trainer survives, and so the island is perhaps unique in the world in staging a race meeting; but having no domestic horses in training—a situation Gallienne himself describes as a ‘bizarre business model’. Therefore, even when trainers based in Jersey, or in the UK or France, have been tempted to enter, the meeting remains entirely dependent on the vagaries of the weather.
“There are obviously wave restrictions on the boats bringing the horses over and, a few years ago, none of the horses were able to travel and we had to call the meeting off.” Nothing, if not resourceful, however, the Club averted complete financial disaster
THERE ARE OBVIOUSLY WAVE RESTRICTIONS ON THE BOATS BRINGING THE HORSES OVER AND, A FEW YEARS AGO, NONE OF THE HORSES WERE ABLE TO TRAVEL AND WE HAD TO CALL THE MEETING OFF.”
TREVOR GALLIENNE – GUERNSEY RACE CLUBCoinShares Les Landes, Jersey.
through persuading those booked into the hospitality marquee to attend a race night in a hotel, instead. Despite all this, there is a resolve to restart, in 2023, the tradition of racing on the island that began over 120 years ago.

A 30-kilometre hop southwest brings you to Jersey’s Les Landes, which has endured similarly turbulent times since COVID-19 struck. “2019 was a very successful year over here”, explains Bunny Roberts, Jersey Race Club President. “And then in 2020, we were hit slam-bang and we had a completely blank year, during which we were still having to pay wages and maintain the course. By 2021, we were in a dire position—the reserves were running out.”
Thankfully, the story takes a happier turn, and in 2022 the race club’s finances are healthy again, and a full and normal fixture list is planned. “We managed to pull it round. We created a very good committee, our patrons stepped up to the plate in a big way, and we are fortunate in that so much of what is done is done voluntarily by people who love the sport. Last year, despite government restrictions at each meeting, we managed to run eight of our nine meetings, albeit later than usual. We were unbelievably lucky with the weather. The crowds supported us, despite the public bar being closed. We allowed people to bring in picnics. For this year, sponsorship is buoyant, and we have eleven £5,000 races, with the minimum now up to £3,000.”
An absence of income from off-track betting or media rights means that the course’s survival depends on creative marketing, with multiple sponsorship offerings, merchandising and a golf day all critical to the financial mix. Roberts takes an upbeat view of the future for Les Landes generally and more specifically of landing the holy grail of media rights income in the future. “It will depend on field size and field quality. Last year the fields were great and the quality of horses in training on the island has improved; we have many rated between 65 and 80. I honestly believe we will get there.”
It is undeniable that, despite relatively modest prize money, there is a healthy interest amongst British-based trainers in taking horses to the islands. In the last pre-pandemic year of 2019, no fewer than nine made the voyage over to Jersey: Neil
Mulholland, Phil McEntee, Eve Johnson Houghton, Michael Appleby, John O’Neill, Richard Guest, Colin Heard, Victor Dartnall and Natalie Lloyd-Beavis. Mulholland was well clear as the most successful, with 13 wins of around £30,000, at an impressive strike rate of over 50%.
In addition, four Brits: David Evans, Michael Appleby, Natalie Lloyd-Beavis and Brian Barr sent runners to Guernsey and collectively made a clean sweep on the day, with Evans picking up three of the day’s races, and Appleby the other two. What, then, is the appeal to these trainers and their owners? “For us it started about eight years ago”, explains Mulholland. “Jim Jamouneau (of Guernsey Race Club) came to the yard one day and said, ‘Why don’t you come to Guernsey?’ We had an owner, Mike Burbage (director of Dajam Ltd), who liked a weekend away, liked the fun, and going to Guernsey for the weekend appealed to him. On our first ever trip, we finished first and second. But every single year we’ve been to the Channel Isles, we’ve had at least one winner, which has made the trip worthwhile. We’ve been Champion Trainer twice. It’s a good weekend away, we enjoy it, and it’s pretty simple really. We go either from Poole, which is the fast boat, or Southampton. We did have to miss one meeting last year because of the weather.”
EVERY SINGLE YEAR WE’VE BEEN TO THE CHANNEL ISLES, WE’VE HAD AT LEAST ONE WINNER, WHICH HAS MADE THE TRIP WORTHWHILE.”
NEIL MULHOLLANDGuernsey Race Club L’Ancresse meeting, 2019 © Martin Gray
What kind of horse is suited to Les Landes? “You need something that travels and is well-balanced”, answers Mulholland. The view is supported by local trainer James Moon, whose yard is far enough from Les Landes that he does not use the training track which runs inside the main track, but rather has his own gallops designed to mimic Les Landes’ unique features. “You have to have an intelligent, balanced and tough horse to win round Jersey, with its undulating surface, stiff finish, hard back stretch with a drop-down and both tight and sweeping bends. It’s great for educating horses both young and old.” Another USP is that there are no starting stalls, with all races being started by flag, making it of particular interest to trainers with recalcitrant starters.
While Brexit has not been relevant to links with Britain, it has affected travel to and from mainland Europe and, for those like the Francophile Moon, it has not been welcome. “It’s totally ruined things”, is Moon’s blunt assessment. “It’s made it massively expensive and all the unnecessary paperwork to fill out—the Coggins test, customs paperwork. We took three over to Pornichet last August. It was a real faff—I’m glad we had a winner and a place.” The hassle, however, is not sufficient to put Moon off making future forays to France. “The prize money’s much better, there’s more choice of races and we have French-breds which qualify for the premiums. They pay out down to sixth place; they look after the owners and the breeders. Since Brexit and COVID, we’ve taken the decision that our breeding stock will stay in France.”


For its part, the Channel Islands Racing and Hunt Club— the governing authority for racing on the islands—is keen to facilitate visiting connections. “We welcome them with open arms”, its honorary secretary, Jonathan Perrée points out, “and try to minimise the bureaucracy as much as possible.”




The low volume of races on the islands and modest prize money beg the question: How do Jersey-based trainers survive? Moon explains, “A lot of the yards over here have split operations, with livery in another yard. The liveries keep the yards buoyant through the winter months.”


For Moon, there is one feature of Jersey’s geography that is of distinct benefit to its trainers. “We’ve got lots of lovely flat beaches, without rocks or holes, so a lot of the trainers will use the sands.” Plans to bring beach racing back to Jersey have been put on the back burner due to COVID-19, but it would be popular with Moon.
“It would be a beautiful, perfect surface for the horses. It would probably ride a bit like Southwell. I think a lot of the trainers would be up for it. And it would be a great spectacle and would also encourage people to come up to the racecourse. It’s definitely the kind of thing they should look at.” The first ever Channel Isles races were on the beach, at St Aubin. Would there not be an elegant symmetry, were beach racing to return to the island, nearly 200 years later?
The enthusiasm and dedication of those who run Channel Islands racing cannot be questioned, and it is to be hoped that its dark days are behind us. I will make a prediction. I suspect that, over the next few years, more British trainers will discover that racing at these beautiful tracks provides all the ‘minivacation’ benefits for their owners without any of the Brexitrelated costs and hassle. With a fair wind—and I use that term advisedly—we could see an explosion of keen international competition on the Channel Isles.
We offer a range of smart and functional clothing to kit out your racing yard staff. Embroidered with your logo, having a branded uniform will give your staff the professional edge. Branded merchandise to promote your racing club or colours.


The first Kentucky-bred winner of The (Epsom) Derby would earn a place in thoroughbred racing lore and even played a small role in the early history of the most successful musical group of the twentieth century. But he nearly didn’t survive his first night of life.
In late March 1951, John Bell and his wife returned from a night out to find that a new foal had arrived at their leased acreage outside Lexington. Its mother, an undersized daughter of American Triple Crown winner War Admiral named Singing Grass, was exhausted, as was the barn foreman who had helped her with a difficult delivery.
The unusually large chestnut colt, by Irish-bred stallion Nasrullah, was having trouble breathing as he lay beside his mother. His right foreleg was tucked awkwardly under his body. Concerned that the newborn might not make it, Bell retrieved a bottle of bourbon whiskey from a desk in the tack room. He took a quick nip for himself and poured the rest of the bottle’s contents down the throat of the struggling foal. The elixir revived the woozy colt, which, fittingly, would be named Never Say Die.
After being taught to carry a rider by Bell and his Jonabell Stables team, the colt was sent to the Newmarket training yard of 72-year-old conditioner Joe Lawson, who had twice been British flat racing’s champion trainer, and had captured most of England’s top races, but for whom the Derby had proven elusive. The colt’s owner, Robert Sterling Clark, heir to the Singer sewing machine company fortune, split his horses between Lawson and another trainer named Harry Peacock. Peacock had won a coin flip to determine which man would receive first choice of Clark’s horses that year. Though he liked the look of Never Say Die, he was not interested in training a son of Nasrullah. Nasrullah was well on his way to one of the most outstanding stud careers in history, but the memory of the stallion’s inability to run to his potential because of temperamental idiosyncrasies was still fresh for many British horsemen.


Never Say Die had been a gangly foal, but he filled out to become a lovely, compact, balanced young colt with a slightly better disposition than that of his notorious sire. Though he never displayed the mental peculiarities on the racetrack that Nasrullah had, Never Say Die did develop a reputation for moodiness and difficulty among the humans that cared for him.
A turf writer for the Daily Express observed that Never Say Die had “an excellent, strong, straight pair of hind legs, even if the joints appear to be somewhat rounded. The captious critics might say that he is over-long of his back. Undoubtedly his best points lie in front of the saddle. There is a rhythmical quality about the set of his neck, shoulder, and powerful forearm which is carried down through the flat knees to a hard, clean underpinning.” The handsome colt’s most notable feature was a prominent white blaze that ran the length of his head—from above his eyes to the tip of his nose.
After some encouraging performances as a two-year-old, including a win in the six-furlong Rosslyn Stakes at Ascot and a third-place finish in the Richmond Stakes at Goodwood, Lawson held guarded hope for Never Say Die at three, and believed a talented young rider named Lester Piggott would help the American colt reach his potential.

If anyone was ever destined to become a jockey, it was Lester Keith Piggott, born in 1935 on Guy Fawkes Day in Oxfordshire. The branches of Piggott’s family tree were littered with jockeys and equestrians, dating back to the 1700s. His grandfather Ernie Piggott had won the Grand National three times as a jockey. Lester’s
grandmother came from a long line of riders that included her two Derby-winning brothers. Lester’s father, Keith, was a successful jockey, winning 500 races over a 30-year career, before becoming a champion trainer of jumpers. Lester’s mother, Iris, also descended from a long line of top-notch jockeys and trainers and was an accomplished rider in her own right.
Lawson took his time with Never Say Die early in his three-yearold season. With 18-year-old Piggott in the irons, the colt began the year with a respectable second-place finish in the Union Jack Stakes at Aintree. He regressed next time out, starting slowly in the seven-furlong Free Handicap at Newmarket, and never factoring in the race. But when stretched out in distance two weeks later for the Newmarket Stakes, Never Say Die gave a performance good enough to convince his owner to give him a shot in the Derby. Though he had tired in the late stages to finish third, he was beaten just a halflength and a head in the 10-furlong test.
Piggott had chosen to ride at Bath that day, and Lawson was inclined to remove him from the Derby-bound colt for his disloyalty. Fortunately for Piggott, the trainer’s first three choices to replace him already had Derby mounts. With the “boy wonder of the turf” again aboard, Never Say Die joined 21 rivals on a chilly and damp afternoon at the starting line for the 175th running of The (Epsom) Derby. Top contenders included Darius, the Two Thousand Guineas victor; Rowston Manor, winner of the Derby Trial Stakes at Lingfield; and the Queen’s colt, Landau. Bookmakers listed Never Say Die as a 33 to 1 long shot. His odds would have been even higher but for the popularity of his young rider and the charm of the colt’s name.
Never Say Die was away quickly from the starting barrier and fell in just behind the first group of front-runners in the early going. He maintained his position, clear of trouble, into Tattenham Corner. Rounding the final turn, Piggott bided time, well off the rail and just behind Rowston Manor, Landau, and Darius. Early in the final straight, he eased his mount to the outside. Passing tiring rivals, Never Say Die roared to the front in mid-stretch and strode on for a two-length win, to the astonishment of hundreds of thousands in attendance and millions listening to the BBC radio broadcast.
With his colt’s Derby conquest, Sterling Clark became the first American owner to win the renowned race with an American horse that he bred himself. In the Derby’s long history, there had






















been only one American-born horse to win—Pennsylvania-bred Iroquois, in 1881. No horse born in Kentucky, the commercial breeding center of the American thoroughbred industry, had ever won the British Classic.
American horsemen were overjoyed. In The Thoroughbred Record, a Kentucky-based weekly publication, columnist Frank Jennings noted that, prior to Never Say Die’s victory, “repeated failure on the part of Americans in the English Derby not only was becoming monotonous but was downright discouraging. Men of less determination and means than Mr. Clark gradually had become reconciled to the idea that a score in the big race at Epsom was virtually impossible with a colt bred and raised on this side of the Atlantic. Never Say Die did a great deal toward changing this thought and at the same time [demonstrated] that American bloodlines, when properly blended with those of foreign lands, can hold their own in the top company of the world.”
The 76-year-old Clark had lived a remarkable life. He had served as a U.S. Army officer during the Spanish-American War and the Boxer Rebellion, led a research expedition through rural Asia, and built one of the finest private collections of European painting masterpieces in the world. In his later years, he created the Sterling and Francine Clark Art Institute near the campus of Williams College in Williamstown, Massachusetts. But nothing provided him greater satisfaction than that historic Derby triumph.

Clark learned the race result via telephone. The winning owner was in a New York City hospital, having chosen not to postpone some scheduled tests. But he was often reluctant to attend the races even when circumstances did not preclude his presence. Large race day crowds made him nervous.
An impromptu champagne celebration was organised in the hospital room, and Clark proposed a series of toasts. A small
group of friends and family first drank to Piggott and Lawson. Then they saluted Bell, the young Kentucky horseman whose fast thinking had helped the Derby champion survive his first night and at whose Jonabell Farm the colt was raised and introduced to a saddle. For Bell, born into a wealthy Pittsburgh family that lost its banking and coal fortune amidst scandal when he was still a child, Never Say Die’s Derby score provided a vital piece of early publicity for his fledgling equine operation that would eventually become one of the most respected in the world and, following a 2001 sale to Sheikh Mohammed bin Rashid Al Maktoum, home to Darley’s North American stallions.
In Liverpool, 230 miles northwest of Epsom, a middle-class housewife named Mona Best listened to the BBC broadcast of the Derby on the family radio. When the results were announced, she jumped for joy. Mona had pawned her jewelry to finance a bet on Never Say Die because she fancied his name. With her winnings, she put a down payment on the house she had long admired, a large 15-room Victorian at 8 Hayman’s Green in the West Derby section of Liverpool.
Before it was fixed up, children called it ‘Dracula’s Castle.’ But it had an unusually spacious cellar where, after renovations, Mona opened the Casbah Coffee Club as a place where her son Pete and his friends could congregate. The idea proved much more popular with the neighbourhood youth than she had imagined, however, and soon the club had 1,000 members who paid an annual fee of 12 ½ pence.
A group of teenaged musicians called the Quarrymen played the opening night in late August 1959, after helping paint the walls and the ceilings that summer. Their set included American rock ‘n’ roll favorites such as Little Richard’s “Long Tall Sally” and Chuck Berry’s “Roll Over Beethoven.” The group’s name was a nod to Quarry Bank High School, which their lead singer, John Lennon, had attended. Paul McCartney, George Harrison, and Ken Brown rounded out the lineup.
Mona was sufficiently impressed with the four guitarists to offer them a weekly engagement at the Casbah. Their compensation was to be three pounds cash, and all the Coca-Cola and crisps that the boys could consume. Soon the young musicians dropped Brown, changed their name to The Beatles, and were looking for a drummer to join them for an extended booking in Germany. Pete became The Beatles’ first regular drummer and played with the band for two years, including their three formative stints in Hamburg, before being replaced by Ringo Starr at the precipice of international celebrity.
Whereas The Beatles were four lads from Liverpool who took America by storm with music that had distinctly American roots, Never Say Die was an American-born horse with a pedigree dominated by European influence that won England’s greatest horse race. Although Never Say Die’s Derby victory did not have the immediate impact on thoroughbred racing that The Beatles had on western culture, his win at Epsom in 1954 was an important signal of change that had been taking place for decades. Vast fortunes with roots in the American industrial expansion of the late-nineteenth and early-twentieth centuries had made it possible for wealthy Americans and their heirs to purchase many of Europe’s top thoroughbreds from their aristocratic owners and import them to America for breeding purposes. By the 1970s, American racehorses produced from those European bloodlines would be winning Europe’s top races with some regularity, and with lasting ramifications for the international thoroughbred industry.



























